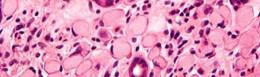

CIRUGÍA GENERAL
William Guzmán





El apéndice se ubica en la confluencia de las tenias cólicas. Entre sus localizaciones más frecuentes, se observan las siguientes: retrocecal ascendente, pélvica e intraperitoneal. Recibe irrigación de la arteria apendicular, rama de la arteria ileocólica, y esta a su vez de la arteria mesentérica superior. El drenaje venoso se dirige al hígado a través de la vena porta.
El mecanismo fisiopatológico es la obstrucción de la luz apendicular, cuya causa varía según el grupo etario (ENARM 2001):
Adultos: coprolitos (ESSALUD 2001, 2004)
Niños: hiperplasia linfoide (folículos de Roux)
Otras causas incluyen tumores, como el mucocele o el tumor carcinoide; parásitos, como los oxiuros y T. trichiura; cuerpos extraños, etc.
FASE CARACTERÍSTICA
CONGESTIVA Obstrucción linfática y venosa (4-6 horas)
SUPURADA Proliferación bacteriana
NECROSADA Obstrucción arterial con consecuente isquemia (ESSALUD 2016)
PERFORADA Complicaciones (peritonitis, abscesos, plastrón)
CLÍNICA GÉRMENES
Estimulación del sistema nervioso simpático: Fibras tipo
C hiporexia → dolor visceral
→ náuseas (ENARM 2005, ENARM 2012)
Estimulación somática: Fibras tipo A dolor parietal
Fiebre Leucocitosis marcada
Dolor al rebote
En esta etapa, aún no se observa proliferación patológica de gérmenes
Bacterias Gram (-) (E. coli)
Bacterias anaerobias (B. Fragilis) (ENARM 2000, ENARM 2005, ENARM 2014)
Bacterias anaerobias (B. Fragilis) (ENARM 2000, ENARM 2005, ENARM 2014)
Las dos primeras fases, congestiva y supurada, se suelen describir como fases no complicadas de la apendicitis, seguida de las fases complicadas, eventos marcados por la isquemia visceral. La perforación del apéndice puede producir complicaciones como peritonitis y formación de masas apendiculares.


Las peritonitis ocurren a partir de las 24 horas de iniciado el cuadro. Pueden ser localizadas o generalizadas, según comprometan un cuadrante o más de uno, respectivamente.
Las masas apendiculares suelen desarrollarse a partir del cuarto día de iniciado el cuadro, en ausencia de peritonitis, y se manifiestan como masas palpables en el cuadrante inferior derecho. Asimismo, pueden presentarse como abscesos o plastrones apendiculares, en caso de presencia o ausencia de contenido purulento en el interior.
La pileflebitis o tromboflebitis portal consiste en la formación de microabscesos hepáticos que ingresan por vía portal. Se trata de la complicación más mortal de la apendicitis aguda.
(ESSALUD 2006)
La cronología de Murphy es la secuencia del cuadro clínico de apendicitis aguda. Inicia con hiporexia, seguida de dolor, náuseas y, posteriormente, la aparición de fiebre. La ausencia de hiporexia, aun cuando sea un síntoma muy inespecífico, puede poner en duda el diagnóstico de apendicitis aguda, así como de un abdomen agudo quirúrgico (ENARM 2014, ENARM 2015) (ESSALUD 2001).



PUNTOS DOLOROSOS:
McBurney: Ubicado entre el tercio externo y tercio medio de una línea recta, entre la espina iliaca anterior derecha y el ombligo. Es el punto de máxima sensibilidad dolorosa. Localiza apéndices de ubicación paracecal. Signo más representativo de la apendicitis aguda (ENARM 2011) (ESSALUD 2011)
MORRIS: Ubicado en el tercio interno y tercio medio de una línea recta, entre la espina iliaca anterior derecha y el ombligo. Identifica localización paraileal.
Lanz: Ubicado entre el tercio lateral y tercio medio de una línea que une las espinas iliacas anterosuperiores izquierda y derecha. Identifica localización pélvica.
Lecene: Ubicado entre dos traveses de dedo por encima y por detrás de la espina iliaca anterosuperior derecha. Identifica localización retrocecal.
SIGNOS DE APENDICITIS AGUDA:
Signo de Rovsing: la presión en fosa iliaca izquierda provoca dolor en fosa iliaca derecha. Signos de Blumberg y Mussy: dolor al rebote, que aparece a partir de las 24 horas de evolución. Signo del iliopsoas: dolor en fosa iliaca derecha al extender la cadera en una persona en decúbito lateral. Identifica localización retrocecal.
Signo del obturador: dolor en fosa iliaca derecha al rotar la cadera flexionada en una persona en decúbito supino. Identifica localización pélvica.

Horn: dolor en FID por la tracción suave del testículo derecho (ENARM 2014).

Hemograma: Leucocitosis con desviación izquierda. Elevación de PCR.
Imágenes: La tomografía contrastada es el estudio de mayor precisión diagnóstica; sin embargo, en las mujeres jóvenes se prefiere la ecografía como estudio inicial (ESSALUD 2010, 2014), ante la probabilidad de una gestación en curso. Hallazgos: diámetro apendicular > 6 mm, pared ≥ 2mm. La presencia de coprolito o líquido libre en cavidad peritoneal refuerza el diagnóstico. La tomografía contrastada también es el estudio de elección ante la sospecha de masa apendicular.

- Otros estudios incluyen radiografías de tórax y examen de orina, con el objetivo de descartar diagnóstico diferencial.


La adenitis mesentérica es el diagnóstico diferencial más común. Frecuente en niños, suele presentarse con antecedente reciente de infección de las vías respiratorias superiores. Las infecciones virales son las más comunes y se manifiestan con linfocitosis relativa en el hemograma.
Otros diagnósticos diferenciales incluyen lo siguiente:
Diverticulitis de Meckel

Infección de vía urinaria (ENARM 2020)
ESCALA DE ALVARADO (ENARM 2017):
Embarazo ectópico Enteritis
Se trata de un score que indica la conducta a seguir en pacientes con cuadro clínico típico y sospecha de apendicitis. Su uso debe tenerse en consideración en ancianos, gestantes y niños, por el cuadro atípico de presentación.
En caso de no poder realizarse tomografía, y ante la duda diagnóstica (Alvarado 4 a 6), se puede considerar la observación del paciente por 12 horas y su reevaluación con un nuevo hemograma.
El tratamiento de la apendicitis es quirúrgico, a través de una apendicectomía por vía abierta o laparoscópica la cual usa CO2 (ENARM 2014, ENARM 2019) (ESSALUD 2001).
La apendicectomía por vía abierta puede realizarse a través de diferentes incisiones
(ENARM 2012):
Incisiones oblicuas (McBurney) o transversas (Rockey-Davis), en ausencia de peritonitis
Incisiones medianas infraumbilicales, en caso de peritonitis (ESSALUD 2008)
La apendicectomía laparoscópica debe evitarse en caso de coagulopatías; sin embargo, ofrece mayores ventajas sobre la abierta, entre ellas: menor dolor posoperatorio, sobre todo en las primeras 24 h (ENARM 2013, ENARM 2012) menor tasa de infección de herida operatoria (ENARM 2017) menor estancia hospitalaria (menores complicaciones)
Una vez realizada la apendicectomía, se debe evaluar y tratar la base apendicular:
Base en buen estado: se usará la técnica de cierre a muñón libre.

Base en mal estado, con perforación: se usará la técnica de cierre de suturas en jareta, considerando la colocación de dren (ENARM 2013)
Peritonitis localizada


Apendicectomía + Drenaje (limpieza) + antibioticoterapia (ESSALUD 2011)
Peritonitis difusa:

Apendicectomía + lavado de cavidad + antibioticoterapia

En ambos tipos de peritonitis, el manejo antibiótico debe durar un mínimo de 5 a 7 días, incluyendo fármacos para anaerobios y gramnegativos. Plastrón apendicular
Antibioticoterapia (ENARM 2017)
Absceso apendicular: drenaje, idealmente percutáneo
En ambos casos de masas apendiculares, la apendicectomía debe ser diferida una vez resuelto el cuadro agudo. La tasa de recidiva es de aproximadamente el 10 %.

En niños e infantes, se suelen manifestar como una obstrucción intestinal. La exploración física sigue siendo el examen más importante para llegar al diagnóstico (ENARM 2006, ENARM 2014, ENARM 2015).
En gestantes, la apendicitis aguda es la primera causa de abdomen quirúrgico. El diagnóstico se hace por ecografía o resonancia magnética. Si las imágenes no están disponibles, se prefiere realizar una laparoscopía exploratoria diagnóstica. El manejo se abordará por apendicectomía laparoscópica. El mejor momento para realizar una laparoscopía es en el segundo trimestre de gestación (ENARM 2021)
En ancianos, la apendicitis aguda se presenta con una mayor tasa de complicaciones. La manifestación clínica no muestra fiebre ni leucocitosis severas, lo que dificulta el diagnóstico (ENARM 2015)
La apendicitis aguda forma parte de las patologías de abdomen agudo inflamatorio, las cuales varían en cuanto a su presentación y evolución. En la evaluación del abdomen agudo, debe evitarse el uso de antibióticos empíricos hasta tener un diagnóstico preciso. El uso de analgesia es controversial, por lo que debe obviarse (ESSALUD 2010); sin embargo, su utilización no debería alterar el diagnóstico con un examen físico adecuado. Cabe mencionar que no todas las patologías de abdomen agudo requieren conducta quirúrgica; en algunos casos, se indicarán manejo médico, antibióticos o procedimientos poco invasivos como drenajes percutáneos o endoscópicos.
Los divertículos son protrusiones localizadas en la pared intestinal. Se clasifican en (ESSALUD 2011): Divertículos verdaderos: frecuentemente, congénitos, y tienen todas las capas de la pared intestinal (mucosa, muscular y serosa).
Falsos divertículos: frecuentemente, adquiridos, y tienen ausencia de la capa muscular.
Generalmente, se localizan en el intestino grueso, a nivel del sigmoides, en la región mesentérica. Sin embargo, también se pueden localizar en el intestino delgado, a nivel del duodeno (segunda y tercera porción) y yeyuno (ENARM 2007, ENARM 2011)
Se manifiestan con más frecuencia a partir de los 50 años. El factor de riesgo más importante es el estreñimiento crónico.
Se denomina así a la presencia de divertículos, localizados con frecuencia en el sigmoides o colon descendente. La mayoría son asintomáticos. En los pacientes sintomáticos, el sangrado rectal es la principal manifestación (ENARM 2002). Se diagnostican, usualmente, por colonoscopía o radiografía contrastada. El manejo no requiere cirugía, salvo complicaciones (ENARM 2013).


El sangrado diverticular, por lo general, procede de divertículos ubicados en el colon ascendente y ciego. Se manifiestan como hemorragias digestivas bajas masivas, siendo la primera causa de estas. Suelen autolimitarse en casos leves; sin embargo, debe optarse por cirugía con resección

intestinal en caso de un sangrado masivo que ponga en riesgo al paciente. Un diagnóstico diferencial de hemorragia digestiva baja masiva corresponde a la angiodisplasia intestinal, localizada también en el hemicolon derecho con más frecuencia (ENARM 2012).


Inflamación de los divertículos por obstrucción de la base diverticular.

DIAGNÓSTICO:
Triada clínica: dolor en lado izquierdo, fiebre y palpación de masa en el lado izquierdo (ENARM 2010, ENARM 2011, ENARM 2018, ENARM 2015) (ESSALUD 2011).
El estudio de imágenes incluye tomografía contrastada (ENARM 2015, ENARM 2018). Está contraindicada la radiografía con contraste por riesgo de diseminación en caso de perforación (ENARM 2013).
Las complicaciones comunes suelen incluir: obstrucción intestinal (ENARM 2011), malignización en casos crónicos, peritonitis, abscesos.
CLASIFICACIÓN DE HINCHEY (ENARM 2015 / ENARM 2018 / ENARM 2019 / ENARM 2015 / ENARM 2021):
GRADO HALLAZGOS MANEJO
I Abscesos pericólicos Antibióticos
II Abscesos pélvicos o en retroperitoneo Drenaje por vía percutánea (ENARM 2020)
III Peritonitis purulenta Cirugía: resección intestinal (ENARM 2015) (ESSALUD 2018)
IV Peritonitis fecaloide
GENERALIDADES:
Los cálculos están formados por colesterol (componente más frecuente) o pigmentos. Los cálculos de colesterol se establecen a nivel de la vesícula biliar, a diferencia de los cálculos pigmentarios marrones, formados en la vía biliar principal. (ESSALUD 2008)
El ayuno, la dislipidemia, la obesidad o la gestación son factores de riesgo que aumentan la generación de cálculos de colesterol. Por otro lado, los cuadros sépticos se relacionan con la formación de cálculos marrones. Un tipo especial de cálculos corresponde a los pigmentarios negros, asociados a cuadros hemolíticos. (ESSALUD 2011)
DIAGNÓSTICO:
Usualmente, la litiasis vesicular es asintomática; sin embargo, pueden desarrollarse complicaciones, como colecistitis, coledocolitiasis, colangitis, pancreatitis y otros derivados de este cuadro. La ecografía abdominal es el método diagnóstico de elección (ENARM 2012, ENARM 2013).
TRATAMIENTO:
La mayoría de cuadros litiásicos, siempre y cuando sean asintomáticos, son de conducta expectante: solo requieren mejorar estilos de vida y reducir factores de riesgo. En cambio, en cuadros sintomáticos, como cólicos recurrentes, colecistitis aguda, pancreatitis aguda, colangitis, coledocolitiasis o aumento de riesgo de cáncer vesicular (cálculos > 3 cm, colecistitis crónica que ha desarrollado vesícula escleroatrófica, vesícula en porcelana, pólipos adenomatosos, colangitis esclerosante primaria), es necesaria la indicación quirúrgica, donde se prefiere la colecistectomía laparoscópica (ENARM 2021)
Corresponde a un dolor persistente en el hipocondrio derecho o epigástrico posprandial, cuya duración es de 30 minutos como máximo. No tiene componente inflamatorio, es decir, no cursa con fiebre, leucocitosis o edema en la pared vesicular. El manejo de elección incluye alivio del dolor con AINES, p.e. ketorolaco, ketoprofeno u opioides. La colecistectomía se indica solo en casos de cólicos recurrentes (ENARM 2015).
Inflamación de la pared vesicular, que incluye su engrosamiento. Puede presentar o no un componente infeccioso asociado.
TIPOS DE COLECISTITIS:
COLECISTITIS LITIÁSICA (90 %): Más frecuente en mujeres. Ocurre por obstrucción del conducto cístico (ENARM 2014, ENARM 2015). Los patógenos más frecuentes son E. coli o Klebsiella. El manejo es quirúrgico, por colecistectomía laparoscópica electiva o de urgencia (ENARM 2010)
COLECISTITIS ALITIÁSICA (10 %): Más frecuente en inmunodeprimidos y pacientes con shock hipovolémico o asociados a uso de inotrópicos (ENARM 2010, ENARM 2018). Los patógenos más frecuentes son E. coli o Klebsiella. El manejo de preferencia es colecistectomía laparoscópica de urgencia (ESSALUD 2001)

COLECISTITIS ENFISEMATOSA (<1 %): Es una forma de presentación de la colecistitis alitiásica, que suele estar asociado a inmunosupresión, más común en diabéticos. El patógeno más frecuente es el Clostridium perfringens, bacteria formadora de gas. El manejo debe ser colecistectomía laparoscópica de urgencia (ESSALUD 2012)
DIAGNÓSTICO (ENARM 2006, ENARM 2011, ENARM 2015, ENARM 2021):

CRITERIOS DIAGNÓSTICOS DE TOKIO 2018
Signos locales de inflamación:
♦ Signo de Murphy
♦ Masa/ Dolor/Hipersensibilidad en el hipocondrio derecho
Signos sistémicos de inflamación
♦ Fiebre
♦ Leucocitosis
♦ PCR elevado
Imagen

♦ Hallazgo en imágenes (ecografía)
A + B → sospecha de CA
A + B + C → confirmación de CA
En ocasiones, puede aparecer ictericia por compresión de la vía biliar principal, producto de la inflamación, así como discreta elevación de las enzimas colestásicas, bilirrubina, enzimas hepáticas, amilasa, lipasa y otros.
El estudio de imágenes de elección es la ecografía. Entre sus hallazgos, se observa:
Pared vesicular mayor o igual a 4 mm
Longitud o ancho de la vesícula mayor o igual a 10 cm x 6 cm, respectivamente Signo de la doble pared
En ciertos casos, puede realizarse colescintigrafía, con alta precisión.
Colecistitis crónica: cuadros repetitivos de colecistitis aguda, con dolor recurrente y hallazgos anatomopatológicos de inflamación crónica, que incluyen:
♦ Vesícula en porcelana: calcificación de la pared vesicular (ENARM 2020)
♦ Vesícula escleroatrófica: atrofia de la vesícula Ambas aumentan el riesgo de cáncer vesicular
Peritonitis
Piocolecisto/Hidrocolecisto
Síndrome de Mirizzi: compresión de la vía biliar por la impactación del cálculo a nivel del bacinete, cursa con ictericia (ENARM 2000)(ESSALUD 2006). Puede evolucionar hacia la formación de fístulas:
♦ Fístula colecisto-duodenal: La más común. El cálculo pasa por el duodeno y recorre todo el intestino delgado, impactando, finalmente, en la válvula ileocecal, lo que genera obstrucción intestinal (íleo biliar) (ENARM 2001, ENARM 2007, ENARM 2017)(ESSALUD 2009).

♦ Fístula colecisto-cólica
ÍLEO BILIAR (ENARM 2007, ENARM 2011, ENARM 2015, ENARM 2016) (ESSALUD 2018, 2019, 2006, 2011, 2013, 2014):
Triada radiológica:
Aerobilia/neumobilia
Signos de obstrucción intestinal
Radiopacidad en la fosa iliaca derecha
Triada clínica:

Antecedente de litiasis vesicular

Antecedente de colecistitis aguda
Hallazgos clínicos de obstrucción intestinal El tratamiento corresponde a la extracción del cálculo (enterotomía + extracción) (ESSALUD 2004).
TRATAMIENTO:
El manejo médico inicial es con antibióticos y antiinflamatorios no esteroideos. Opcionalmente, se indicará colecistectomía laparoscópica (ENARM 2002), que puede desarrollarse en diferentes momentos:
Urgente: dentro de las 6 a 12 horas de evolución. Tiene las siguientes indicaciones:
♦ cuadro clínico de menos de 72 horas de evolución
♦ complicaciones agudas (peritonitis, perforación vesicular)


♦ inmunosuprimidos
Temprana: dentro de las primeras 72 horas de evolución. Indicado, principalmente, en cuadros leves, no complicados, de menos de 72 horas de evolución (ESSALUD 2018)
Diferida: a las 6 semanas posteriores al inicio del cuadro clínico.
La colecistectomía laparoscópica es abordaje de elección, siendo una contraindicación absoluta los trastornos de coagulación (ESSALUD 2001). En casos de colecistitis aguda severa con compromiso multiorgánico, se prefiere realizar colecistostomía, que consiste en el drenaje de la vesícula con la colocación de un catéter o sonda (ENARM 2006).

La colecistectomía tiene un espectro amplio de variantes quirúrgicas y su aplicación depende del criterio del cirujano. En casos de compromiso de la zona proximal e imposibilidad de identificar o disecar el triángulo de Calot, una opción recomendable es practicar una colecistectomía parcial con sección de infundíbulo (ENARM 2020).
Presencia de cálculos en el colédoco, también llamada litiasis coledociana o litiasis de la vía biliar principal. Los cálculos primarios se originan en la vía biliar y se componen de bilirrubinato de calcio; mientras que los cálculos secundarios se originan en otros lugares, generalmente, en la vesícula, y se componen de colesterol. Los pacientes con litiasis vesicular desarrollan coledocolitiasis en un 10 %.
La coledocolitiasis residual ocurre luego de una colecistectomía. Se debe sospechar coledocolitiasis residual en un paciente con coledocolitiasis y antecedentes de colecistectomía de menos de 2 años (ENARM 2002, ENARM 2011).
Las obstrucciones de la vía biliar principal incluyen como causas a las parasitosis (Ascaris lumbricoides), neoplasia de la vía biliar, tumores periampulares, estenosis y otras causas.

Clínica: ictericia, dolor tipo cólico en el hipocondrio derecho o epigastrio.
Laboratorio (ENARM 2013):
↑ Bilirrubinas totales a predominio directo
(≥4)
↑ FA, ↑GGT ≥ 50 % del valor basal
↑ Amilasa, lipasa, TGO, TGP
Imágenes
El estudio inicial debe ser la ecografía, con la finalidad de ver el diámetro de la vía biliar. El valor normal es de 6 a 7 mm
El estudio de elección es la colangiografía (ENARM 2010, ENARM 2018), que puede ser:
♦ Colangiografía endoscópica (CPRE-Colangiopancreatografía retrógrada endoscópica). Es el estudio de elección (ENARM 2006) Tiene riesgo de desarrollar pancreatitis (complicación más frecuente), perforación, hemorragia y otros.


♦ Colangioresonancia (CRM-Colangiografía por resonancia magnética): es menos invasivo (ENARM 2020).
♦ La colangiografía intraoperatoria es una opción a tomar en cuenta en caso de que el paciente se encuentre ya programado para un procedimiento quirúrgico.

TRATAMIENTO:
El manejo de elección es la extracción del cálculo más esfinterotomía por vía endoscópica (CPRE + esfinterotomía) (ENARM 2002, ENARM 2005, ENARM 2015, ENARM 2019, ENARM 2021).
COMPLICACIONES:
♦ Colangitis (ESSALUD 2008)
♦ Pancreatitis
GENERALIDADES:
Proceso inflamatorio de la vía biliar principal, usualmente secundario a obstrucción.
CAUSAS:
Benignas: coledocolitiasis (más común), parasitosis, quiste de colédoco, estenosis de la vía biliar, etcétera.
Malignas: tumores periampulares
Gérmenes asociados: E. coli, Klebsiella, Enterobacter (ENARM 2015)
DIAGNÓSTICO (ENARM 2007, ENARM 2015, ENARM 2020, ENARM 2021) (ESSALUD 2008, 2009, 2011):
Triada de Charcot: fiebre, ictericia y dolor en el hipocondrio derecho.
Pentada de Reynolds: fiebre, ictericia, dolor, más depresión del SNC más shock séptico. Representa una colangitis aguda severa (ENARM 2004, ENARM 2012, ENARM 2010, ENARM 2009).

CRITERIOS DIAGNÓSTICOS DE TOKIO 2018
A. Signos de colestasis: ↑bilirrubina, ↑FA, ↑GGT, ictericia
B. Signos sistémicos de inflamación: fiebre, leucocitosis, ↑PCR
C. Imágenes: colangiografía (CPRE o CRM) (ENARM 2018)
A + B → sospecha de colangitis
A + B + C → diagnóstico de colangitis
SEVERIDAD SEGÚN GUÍA DE TOKIO 2018
Leve: no hay compromiso sistémico y responde a antibióticos.
Moderado: no hay compromiso sistémico; no responde a antibióticos. Leucocitosis severa o leucopenia. Edad>75 años, fiebre elevada. Hipoalbuminemia <70% de rango normal.
Severo: compromiso sistémico o multiorgánico (ESSALUD 2015, 2019):

♦ Neurológico: depresión SNC
♦ Cardiovascular: shock que requiere manejo inotrópico
♦ Renal: oliguria, ↑ Cr
♦ Hepático: ↑TP, prolongación INR
♦ Hematológico: plaquetopenia
♦ Respiratorio: PaO2/FiO2 <300

Consiste en drenaje de la vía biliar. El drenaje puede realizarse por las siguientes vías: Endoscópica: CPRE. Se prefiere en pacientes en estadio I o II (ENARM 2017).
Quirúrgico: Se prefiere en pacientes en estadio III. Incluye la colecistostomía, exploración de la vía biliar con drenaje Kehr, drenaje percutáneo.(ESSALUD 2001, 2004, 2019)

COMPLICACIONES:
La complicación más frecuente es la formación de abscesos hepáticos piógenos que ingresan al hígado por vía biliar ascendente (ENARM 2005, ENARM 2010, ENARM 2011, ENARM 2012, ENARM 2015).

La peritonitis es una complicación del abdomen agudo inflamatorio, que consiste en la irritación del peritoneo parietal, ocasionado por contenido intestinal, pancreático. Otras sustancias que generan irritación parietal en menor proporción son la orina y sangre.
PRIMARIA O ESPONTÁNEA: Se origina en el mismo peritoneo. No existe perforación visceral y es monobacteriana. Los patógenos más frecuentes son E. coli y Klebsiella, sobre todo en pacientes cirróticos o renales. Otros: Streptococo y Estafilococo. El tratamiento es antibiótico (ESSALUD 2016)
SECUNDARIA: Es la más común, existe perforación visceral y es polibacteriana. La causa más frecuente es peritonitis secundaria a apendicitis. El tratamiento es quirúrgico. Es usual la formación de abscesos intraabdominales (ESSALUD 2013)
TERCIARIA: Corresponde a una peritonitis primaria o secundaria resistente o recurrente al tratamiento, principalmente, en estados de inmunosupresión. Causado por hongos. El tratamiento es con antibióticos y manejo de la inmunosupresión.
Abscesos intraabdominales

Pueden ser subfrénicos, subhepáticos o del espacio de Morrison, parietocólico, del lecho apendicular, del fondo de saco de douglas o retrovesicales. Los más comunes son los subfrénicos por peritonitis como complicación de una apendicitis. El diagnóstico es con tomografía. El tratamiento consiste en drenar el absceso; si es de tamaño pequeño, puede manejarse con antibióticos (ESSALUD 2016)
De la herida quirúrgica: ocurren, sobre todo, en cirugías abiertas.
1.er día: hematomas (contenido sanguíneo)
2.do – 3.er día: seromas (contenido linfático) (ENARM 2003)
4.to día: la herida puede ser dehiscencia, infección de sitio operatorio (ISO), rechazo
de cuerpos extraños. Fascitis necrotizante (ESSALUD 2019)
Pulmonares: las más frecuentes son las atelectasias. Se dan, sobre todo, en cirugías laparoscópicas (ESSALUD 2008, 2019)
1.er día: atelectasias (ENARM 2010, ENARM 2012) (ESSALUD 2003, 2012)
2.do día: atelectasias, neumonía, ITU (ENARM 2022)
3.er día: flebitis (infección del sitio del catéter)
4.to día: infecciones del sitio operatorio (ISO) (ESSALUD 2013)
Pueden tener diferentes localizaciones:

Piel
Tejido celular subcutáneo: la zona más frecuente (ESSALUD 2009, 2018)
Tejidos blandos profundos (aponeurosis, músculos) Órgano o espacio (espacios intraabdominales)
CAUSAS O FACTORES DE ISO (ESSALUD 2007):
Heridas contaminadas o sucias
Paciente malnutrido
Paciente inmunosuprimido
Mala asepsia
Mala técnica de lavado de manos
Uso de sustancias químicas para disminuir la presencia de gérmenes en una superficie:
Piel o mucosas → antisepsia

Tejido inanimado → desinfección
Eliminación completa del 100 % de formas de vida, incluyendo bacterias, hongos, virus→ esterilización.
Conductas para mantener la limpieza de una superficie→ asepsia.
Dolor abdominal ocasionado por obstrucción vascular que causa isquemia intestinal.
Eventos agudos: son los más frecuentes
Compromiso del Intestino delgado o isquemia mesentérica: la causa más frecuente es la embolia arterial por antecedente cardiovasculares (Ej, valvulopatías, cirugías cardiacas)(ESSALUD 2012). El paciente cursa con dolor agudo y súbito y la mayoría tiene antecedentes cardiovasculares. El diagnóstico se hace por AngioTEM o angiografía y el tratamiento dependerá del grado de severidad de la necrosis (ENARM 2020).
Compromiso del intestino grueso o colitis isquémica: la causa más común es por shock hipovolémico (Ej,. en politraumatizados o gran quemados). Generalmente ocurre a nivel del colon izquierdo (colon descendente y ángulo esplénico). El paciente suele referir dolor en flanco izquierdo asociado con signos de shock hipovolémico. El diagnóstico es por colonoscopia. Eventos crónicos:
Angina intestinal: por formación de placas ateromatosas. Síndrome de compresión de tronco celiaco: los vasos sufren compresión externa (Ej,. por uso de corset o fajas ajustadas).
Infartos blancos o anémico: ocurren por obstrucción arterial, suele ocurrir en tejidos laxos (Bazo, riñón) (ENARM 2007)
El bazo es la víscera sólida que con más frecuencia sufre isquemia.
Recuerda
Un caso clásico de colitis isquémica es un paciente que presenta diarrea sanguinolenta y dolor abdominal intenso después de la reparación de un aneurisma aórtico abdominal.
Infartos rojos: ocurren por obstrucción venosa, el órganos más frecuentemente comprometido es el hígado seguido de los pulmones.
Figura 31. Colonoscopia. Se puede observar una mucosa pálida y una pérdida del patrón vascular. Estos hallazgos son compatibles con la colitis isquémica.
Ocurre principalmente en adultos > 60 años
Los jóvenes con fibrilación auricular, vasculitis (Poliarteritis nodosa) o estados de hipercoagulabilidad también pueden verse afectados

Isquemia mesentérica aguda: 0,1% de todos los ingresos hospitalarios
Embolia arterial aguda es la causa más común Más comúnmente involucra la arteria mesentérica superior Generalmente resultante de una fibrilación auricular, infarto de miocardio, enfermedad cardíaca valvular, o endocarditis
El paciente cursa con dolor súbito. Dolor periumbilical desproporcionado a los hallazgos físicos.
Náuseas y vómitos
Diarrea: sanguinolenta en etapas posteriores (heces de gelatina de grosella)
Intestino gangrenoso: sangrado rectal y signos de sepsis (p. Ej., Taquicardia, hipotensión)
El diagnóstico es por AngioTEM (prueba confirmatoria) o angiografía (alternativa) (ENARM 2020)
Manejo definitivo
Necrosis
en isquemia mesentérica.
Hallazgo intraoperatorio: Las asas del intestino delgado aparecen distendidas e hiperémicas, muy probablemente debido a íleo paralítico. La pared de varias asas intestinales en la sección inferior de la imagen tiene una decoloración gris pronunciada, lo que indica necrosis.

Medidas generales: líquidos intravenosos, sonda nasogástrica, analgésicos y antibióticos de amplio espectro.

Laparotomía de emergencia: en el caso de signos de isquemia avanzada (Peritonitis, sepsis) o paciente hemodinámicamente inestable:
♦ Embolectomía quirúrgica abierta o derivación de la arteria mesentérica según la causa de la oclusión.
♦ Resección de segmentos intestinales necróticos.
Revascularización endovascular: en el caso de pacientes hemodinámicamente estables sin signos de avanzada isquemia
♦ Angioplastia con balón y colocación de stents
♦ Trombectomía farmacológica (trombolítica) y / o mecánica basada en catéter
♦ Infusión de un vasodilatador (Papaverina) durante la arteriografía para aliviar la oclusión y el vasoespasmo
♦ Anticoagulación con heparina en casos de trombosis venosa
Isquemia mesentérica aguda: tasa de mortalidad de 60-80%.
Aneurisma: dilatación ≥ 50% del diámetro.
Aneurismas de aorta abdominal:
• Leve: ≥ 3 cm de diámetro
• Moderado: 4 - 4,5 cm de diámetro
• Severo: ≥ 5,5 cm de diámetro
Los aneurismas aórticos abdominales son los más frecuentes y afectan en un 5 a 10% de la población, la mayoría son casos leves y no generan síntomas. La localización infrarrenal es la más común. El principal factor de riesgo de ruptura es un diámetro ≥ 5,5 cm seguido de hipertensión arterial y tabaquismo. Las principales manifestaciones clínicas en un aneurismas abdominal roto es el dolor súbito seguidos de una descompensación hemodinámica. El manejo dependerá de la gravedad, en los aneurismas no rotos se opta por el uso de prótesis o stent, en los aneurismas rotos el manejo es quirúrgicos.



Es la interrupción del paso normal a través del intestino.

Obstrucción intestinal mecánica: la interrupción del paso normal a través del intestino debido a una barrera estructural (Un tumor, adherencias)
Íleo paralítico (obstrucción intestinal funcional): deterioro funcional temporal de la peristalsis en ausencia de una obstrucción mecánica.
Obstrucción del intestino delgado:
Se debe sospechar como primera causa a las bridas/adherencias en pacientes con antecedentes quirúrgicos y como segunda causa frecuente a las hernias. El nivel de obstrucción para ambas causas es a nivel del íleo (ENARM 2015, ENARM 2019, ENARM 2018, ENARM 2014, ENARM 2009, ENARM 2016)(ESSALUD 2001, 2003, 2011, 2012, 2013, 2014, 2016).

Obstrucción del intestino grueso:
Los vólvulos son la primera causa seguida de las neoplasias, sobre todo en países no desarrollados. (ENARM 2004)(ESSALUD 2010).
Primeras causas de obstrucción según grupo etario:
Adultos: bridas/adherencias
Niños (< 3 años): intususcepción
RN: atresias intestinales
La brida está formada de tejido vascularizado, también llamado cuerda y es de aparición tardía a diferencia de las adherencias que son avasculares y de aparición temprana.
Obstrucción intestinal → ↑ presión intraluminal, que conduce a la siguiente:
Distensión abdominal gaseosa → secuestro de líquidos dentro de las asas intestinales distendidas (tercer espacio) → deshidratación e hipovolemia
Vómitos → pérdida de líquido y Na +, K +, H + y Cl - → Alcalosis metabólica con hipocloremia, hipopotasemia e hipovolemia (ESSALUD 2015)
Compresión de venas y linfáticos intestinales → edema de la pared intestinal → compresión de arteriolas y capilares intestinales → isquemia intestinal, que conduce a:
♦ ↑ Permeabilidad de la pared intestinal → translocación de microbios intestinales a la cavidad peritoneal → sepsis
♦ Necrosis y perforación de la pared intestinal → peritonitis
Metabolismo anaeróbico y lisis de células isquémicas
→ acumulación de ácido láctico y liberación de K + intracelular → acidosis metabólica e hiperpotasemia
Según el origen
Mecánicas: requieren conducta quirúrgica

No mecánicas: son de causa médica, (Ej,. por narcóticos), neurológica, infecciosa (ENARM 2014).
Según la localización
Intraparietal o intrínseca: tumores, enfermedades inflamatorias (Ej,. Diverticulitis) (ENARM 2014).
Extraparietal o extrínseca (más comunes): hernias, bridas, vólvulo, invaginaciones.
Intraluminal: íleo biliar, fecalomas, bezoar, cuerpos extraños (ENARM 2014)
La obstrucción intestinal se caracteriza por la presencia de dolor tipo cólico, vómitos, distensión abdominal, ausencia de eliminación de flatos. Los ruidos hidroaéreos inicialmente se hacen muy intensos por la lucha intestinal, posteriormente se debilitan hasta llegar a ser ausentes. Las características de cada signo y síntoma difieren de acuerdo a la localización de la obstrucción, pudiendo ser alta, media o baja, proximal o distal. La presencia de fiebre puede sugerir isquemia intestinal y cuadros complicados (ESSALUD 2007, 2012)
IMÁGENES
Radiografía abdominal simple frontallateral y bipedestación (ENARM 2006).
Hallazgos: niveles hidroaéreos, monedas apiladas (ENARM 2014).
LABORATORIO
Hemograma: la presencia de leucocitos con desviación a la izquierda sugiere estrangulamiento del segmento afectado.
Obstrucción intestinal no complicada (no fiebre, leucocitosis): colocar SNG más fluidoterapia, independiente si la obstrucción es parcial o completa (ESSALUD 2013, 2014, 2018, 2019)(ENARM 2001, ENARM 2011, ENARM 2016, ENARM 2017, ENARM 2018, ENARM 2019)
Obstrucción intestinal complicada (fiebre, leucocitosis): laparotomía (ENARM 2014)


En adultos es más frecuente los vólvulos del intestino grueso. Por el contrario, en niños es más común el vólvulo de intestino delgado cuando hay malrotación intestinal. Los vólvulos se originan por torsión intestinal en sentido antihorario.
Edad:
♦ Vólvulo sigmoideo: ∼ 70 años
♦ Vólvulo cecal: 40 a 60 años
♦ Malrotación intestinal y vólvulo del intestino medio: recién nacidos y lactantes

Figura 35. Vólvulo de sigmoides. El colon sigmoide gira sobre su eje mesentérico, lo que provoca una obstrucción intestinal mecánica y un compromiso vascular
Sexo
♦ Vólvulo sigmoideo: ♂ > ♀
♦ Vólvulo cecal: ♀ > ♂
Los factores de riesgo incluyen edad avanzada, estreñimiento crónico, dieta, muy común en zonas altoandinas. Estos factores de riesgo aumentan la probabilidad que el mesenterio se alargue y tienda a rotar sobre su propio eje.
La localización más frecuente es a nivel del colon sigmoides. Otros lugares son el ciego, el colon transverso y ángulo esplénico.
La localización más frecuente es el colon sigmoides (80%) (ESSALUD 2003). Otros lugares son el ciego (15%), el colon transverso (3%) y ángulo esplénico (2%).
Torsión del intestino sobre su eje:
Obstrucción intestinal mecánica de circuito cerrado → acumulación de gas y heces dentro del asa → aumento de la presión intraluminal → alteración de la perfusión capilar del intestino → estrangulación intestinal, isquemia y gangrena
Torsión del pedículo vascular mesentérico → oclusión / trombosis de los vasos mesentéricos → estrangulación intestinal, isquemia y gangrena
Clínica de obstrucción intestinal baja: dolor, distensión abdominal marcada, vómitos fecaloides, RHA con tomo aumentado (timbre metálico) (ENARM 2009, ENARM 2011).
Imágenes:
♦ Radiografía abdominal simple: grano en café o asa en omega, que refleja la dilatación sigmoidea
♦ Radiografía abdominal con contraste: signo de pico de pájaro.
Reanimación inicial: líquidos intravenosos; corrección del desequilibrio ácido-base y electrolítico; ayuno enteral; colocación de una sonda nasogástrica.

Devolvulación por colonoscopía, está indicado en vólvulos recurrentes. Si el manejo falla se realizará manejo quirúrgico por emergencia.
En caso el paciente responda al manejo se realizará un manejo quirúrgico electivo.

El manejo en caso el paciente curse con fiebre, leucocitosis o un cuadro de más de 12 horas de evolución será quirúrgico (resección sigmoidea) asociado a anastomosis o colostomía tipo Hartmann. La anastomosis está indicada en condiciones en las cuales no haya riesgo de dehiscencia. Por el contrario, se indica colostomía tipo Hartmann en condiciones que impiden la cicatrización como shock, sepsis, malnutrición o gangrena extensa.



Hernia: protrusión de cualquier víscera desde un orificio natural. Debe diferenciarse de las eventraciones cuyo origen es adquirido por cirugía previa (ESSALUD 2011) (ENARM 2015, ENARM 2013).




Componentes: saco herniario, cuello o anillo herniario y contenido.
Inguinal: es la más frecuente (ENARM 2010)
Epigástrica
Umbilical
Lumbares
Spiegel: hernia que protruye a través de la línea semilunar (borde externo de los rectos (ENARM 2003, ENARM 2009, ENARM 2015)
Femoral o crural
Littre: Contiene al divertículo de Meckel (ENARM 2001, ENARM 2011)(ESSALUD 2003, 2013) Richter: Contiene sólo parte de la pared intestinal (ENARM 2010) (ESSALUD 2016)
Amyand: Contiene al apéndice en un saco inguinal
Deslizada: Cuando el saco está formado por una víscera (ENARM 2014, ENARM 2020)
Hernias reductibles:
Coercibles: una vez reducido el contenido permanece dentro del abdomen.
Incoercible: a pesar de poder reducirse con facilidad, vuelven a salir por el orificio inguinal rápidamente (ESSALUD 2016)
Hernias irreductibles:

Incarceradas: tienden a generar obstrucción intestinal, no hay compromiso vascular (ENARM 2014).
Estranguladas: existe compromiso vascular (color oscuro a nivel de la piel, fiebre, leucocitosis). Deden operarse de emergencia (ENARM 2020) (ESSALUD 2001, 2011)
¡No se debe intentar la reducción manual de la hernia inguinal si hay signos de estrangulación!
Es frecuente en mujeres gestantes, puérperas (ENARM 2011)(ESSALUD 2019, 2013). Contiene epiplón e intestino delgado. El tratamiento dependerá del tamaño de la hernia: Hernia < 1 cm → Rafia de la hernia
Hernia > 1 cm o de causa quirúrgica o asociado a obesidad→ colocación de malla.
En niños el manejo es observación, se considera la cirugía si la hernia tiene > 2 cm o el niño es mayor de 4 años.
Se considera hernia falsa (sin contenido), causa dolor intenso (ENARM 2002). El tratamiento es quirúrgico. Tienen baja tasa de recurrencia.

Asociado a antecedentes quirúrgicos, sobre todo, post cirugías de emergencia abiertas con incisión mediana supraumbilical (ENARM 2016).
Factor de riesgo: obesidad, malnutrición, infecciones del sitio operatorio.

Es la hernia más frecuente, predomina en hombres. Tiene contenido al intestino delgado (íleon) y se manifiesta como tumoración. (ESSALUD 2016)
TIPOS DE HERNIA INGUINAL (ESSALUD 2005, 2006, 2007, 2011, 2012, 2013, 2015, 2018)

Protruye por el triángulo de Hesselbach Protruye por el anillo inguinal profundo Medial a los VEI Lateral a los VEI Debilidad de pared posterior Persistencia del conducto peritoneo-vaginal Adquirida, adultos mayores de 40 años Congénita. Se ve en infantes y adultos Se suele reducir al decúbito No se reduce al decúbito, reaparece con esfuerzos. Asociado a criptorquidia, hidrocele

Llega al escroto
Triángulo Hesselbach
Medialmente: músculo recto del abdomen

Lateralmente: vasos
epigástricos inferiores
Inferiormente: ligamento inguinal
Asociado a la multiparidad. Es común en mujeres 40 años (ENARM 2009). Se localizan por debajo del ligamento inguinal (ENARM 2012). Son las hernias con mayor riesgo de estrangulamiento. (ESSALUD 2006, 2008)
Clasificación de Nyhus (ENARM 2016, ENARM 2019, ENARM 2021):
I Hernia inguinal indirecta con anillo profundo normal
II Hernia inguinal indirecta con anillo profundo dilatado, vasos epigástricos no desplazados y pared posterior intacta
III Defectos de la pared posterior
A Hernia inglinal directa
B Hernia inguinal indirecta con anillo profundo muy dilatado, vasos epigástricos desplazados y compromiso de la FT
C Hernia crural
IV Hernias recurrentes


A Directas B Indirectas C Crurales D Mixtas
TRATAMIENTO
El manejo dependerá del grupo etario
Niños → Herniotomía (ligadura del saco herniario). Técnica: de McKay o Potts. Adultos → Invaginación del saco herniario más refuerzo de la pared posterior [herniorrafías o hernioplastías] (ENARM 2015).

GENERAL Herniorrafías (con tensión):

Bassini: unión del tendón conjunto con ligamento inguinal (ENARM 2010)(ESSALUD 2002).
Mc Vay: unión del tendón conjunto con el ligamento de Cooper (ENARM 2007).
Shouldice: primero se sutura la fascia transversal con posterior cirugía de Bassini. Hernioplastias (sin tensión) (ENARM 2013):
Anteriores: colocación de malla de polipropileno por encima del canal inguinal.
♦ Técnica: Liechtenstein (de elección) (ENARM 2005, ENARM 2011, ENARM 2014, ENARM 2015) (ESSALUD 2006)
Posteriores o preperitoneales: colocación de malla de polipropileno por detrás del canal inguinal.
♦ Técnica: Nyhuss (en recurrencia) y Stoppa (en hernias bilaterales).

♦ Técnica laparoscópica: TAPP y TEPP.
Fascia abdominal superficial con aponeurosis del músculo oblicuo abdominal externo
Músculo transverso abdominal
Músculo oblicuo interno del abdomen
Fascia transversal


Peritoneo

Heridas por laceración en el conducto anal, ubicadas por debajo de la línea pectínea/ dentada.
Línea media posterior (90%) 6 en punto en posición de litotomía y línea media anterior (10%) (ENARM 2017)
Primario (debido a un trauma local)
Espasmo crónico / aumento del tono en el esfínter anal interno
Baja ingesta de fibra
Estreñimiento crónico (más común) o diarrea
Sexo anal
Parto vaginal

Secundario (debido a una enfermedad subyacente)
Cirugía anal previa (Posible estenosis del canal anal)
Enfermedad inflamatoria intestinal (Enfermedad de Crohn)
Enfermedad granulomatosa (Tuberculosis)
Infecciones (Clamidia, VIH)
Malignidad (Leucemia)
El espasmo del esfínter anal interno expuesto provoca un tirón a lo largo de la laceración, lo que dificulta la cicatrización y empeora la extensión de la laceración con cada evacuación intestinal. El dolor resultante provoca la evitación voluntaria de la defecación y el estreñimiento, lo que empeora la distensión de la mucosa anal.
Se cree que la comisura posterior tiene un riego sanguíneo muy deficiente, lo que la predispone a la isquemia (agravada por la mala perfusión durante el aumento de la presión anal).


Dolor muy intenso, lancinante, que empeora la defecar asociado a leve sangrado (ENARM 2002, ENARM 2007, ENARM 2009, ENARM 2010, ENARM 2013) (ESSALUD 2009, 2012, 2013).
Fases
Aguda (menor de 6 semanas de evolución): sangrando asociado a dolor Crónica (mayor de 6 semanas de evolución): úlcera con hemorroide centinela (por arriba) y pliegue cutáneo (por debajo).
Fase aguda: baños de asiento, ablandadores de heces, analgésicos y dieta (ESSALUD 2019)
Fase crónica: Relajar el esfínter anal interno mediante la esfinterotomía lateral interna (de elección) (ENARM 2003, ENARM 2011, ENARM 2013, ENARM 2018, ENARM 2019) o toxina botulínica (en pacientes con riesgo de incontinencia fecal).
Figura 52. Esfinterotomía lateral interna
Son causados por la dilatación de plexos venosos internos (hemorroides interna) o externo (hemorroides externa). Las más frecuentes son las primeras.

Obesidad, multiparidad, estreñimiento crónico y otras causas que aumenten la presión intraabdominal (ENARM 2011).

Las hemorroides se clasifican como internas, externas o mixtas.
Hemorroides internas
Se desarrolla por encima de la línea dentada, que no está inervada por nervios cutáneos; la distensión no causa dolor.
El prolapso de las hemorroides internas con posible encarcelamiento y estrangulamiento, puede causar dolor al desencadenar un espasmo del complejo del esfínter anal. → posible isquemia y necrosis de hemorroides internas → empeoramiento del espasmo del complejo del esfínter anal → posible trombosis hemorroidal externa → dolor cutáneo
Las hemorroides internas sangrantes y / o prolapsadas irritan la piel perianal sensible → picazón perianal
Hemorroides externas
Se desarrollan por debajo de la línea dentada, que está inervada por nervios cutáneos; distensión de esta piel inervada debido a un coágulo o edema produce un dolor intenso
Cuadros agudos con trombosis generan dolor, con una duración de 7-14 días
En caso de las hemorroides internas (clasificación de Goligher) (ESSALUD 2004)
Grado I: las hemorroides no se prolapsan, son reversibles, se ubican por encima de la línea dentada y pueden visualizarse en la anoscopia
Grado II: prolapso de hemorroides con esfuerzo, pero se reducen espontáneamente
Grado III: prolapso de hemorroides con esfuerzo y solo se pueden reducir manualmente
Grado IV: prolapso irreducible
GRADOS CLÍNICA MANEJO

I
II
III
• Sangrado (ENARM 2011)
• No hay prolapso
• Sangrado
• Prolapso con reducción espontánea
• Sangrado
• Prolapso con reducción manual
• Sangrado
• No se reduce.
IV
• Puede generar estrangulamiento (trombosis) que se traduce en una masa violácea dura que genera intenso dolor.
Baños de asiento + dieta rica en fibra
Ligadura con bandas elásticas/ fotocoagulación + escleroterapia (ENARM 2020)
Cirugía: Hemorroidectomía cerrada (ENARM 2017) (ESSALUD 2007)
Cirugía: Hemorroidectomía abierta (ENARM 2015, ENARM 2016)
En casos de trombosis el manejo inicial es drenaje seguido de cirugía (ENARM 2011, ENARM 2015) (ESSALUD 2016)

Infecciones de las criptas perianales
Sexo: ♂ > ♀ (2: 1)
Causa más común: obstrucción del flujo e infección de las glándulas de la cripta anal (90% de los casos)
Causas menos comunes
♦ Enfermedad intestinal inflamatoria crónica (EII): enfermedad de Crohn, colitis ulcerosa (con menos frecuencia)
Localización
Perianal (más común)
♦ Absceso debajo de la piel perianal
♦ No atraviesa el esfínter externo
Edad: media de 40 (rango entre 20 y 60 años)
♦ Infecciones agudas del tracto gastrointestinal: p. Ej., Diverticulitis complicada, apendicitis aguda

♦ Proctitis inducida por radiación
♦ Iatrogénico
♦ Cuerpo extraño

♦ Malignidad: p. Ej., Cáncer colorrectal
Isquiorrectal: absceso debajo del músculo elevador del ano.
Interesfinteriano: absceso entre los esfínteres interno y externo.
Supraelevador (menos común): absceso por encima del músculo elevador del ano
Figura 55. Localizaciones de los abscesos Absceso supraelevador
Absceso isquiorrectal
Absceso interesfinteriano
Absceso perianal
Masa flogótica que genera dolor pulsátil asociado a fiebre, genera incapacidad (ENARM 2011), prurito y malestar perianal sordo y exacerbación del dolor al sentarse y defecar. Examen rectal digital: masa fluctuante, indurada, dolor con la presión.
(ESSALUD 2014)
Tomografía computarizada / resonancia magnética o ecografía anal: pruebas de confirmación para abscesos más profundos
Drenaje quirúrgico
Postoperatorio
Baños de asiento
Formación de fístulas.
Analgésicos y ablandadores de heces
Antibióticos: indicado en individuos inmunodeprimidos

Trayecto anormal entre el conducto anorrectal y la piel usualmente por un absceso previo.
Tenemos la clasificación de Parks:
Interesfinteriano (tipo I de Parks) es la más frecuente (ENARM 2002)(ESSALUD 2007,2015)
Curso: a lo largo del espacio anatómico entre el esfínter interno y externo
Apertura: piel perianal y / o recto
Transesfinteriana (tipo II de Parks)
Curso: penetra el músculo esfínter externo del ano hacia la fosa isquiorrectal
Apertura: piel perianal
Supraesfinteriano (tipo III de Parks)
Curso: asciende caudalmente dentro del espacio interesfinteriano, penetra el músculo elevador del ano y sigue caudalmente hacia la fosa isquiorrectal
Apertura: piel perianal
Extraesfinteriano (tipo IV de Parks)
Curso: desde la apertura interna de la ampolla rectal (por encima de la línea dentada) a través de los músculos elevadores del ano.

Apertura: piel perianal
Fístula extraesfinteriana
Fístula transesfinteriana
Fístula transesfinteriana

Fístula supraesfinteriana
Fístula interesfinteriana
Según regla de Goodsall se dividen en: Anteriores (+ frecuente): rectas, cortas y únicas (ENARM 2009) (ESSALUD 2018) Posteriores: largas, múltiples, ramificadas.

Secreción fétida (ENARM 2015) y dolor durante la defecación
Ecoendoscopía (de elección) / Fistulografía (ENARM 2020)
Fistulotomía (las bajas). Fistulectomía (las altas)


DEFINICIÓN:
Protuberancia de cualquier estructura / órgano abdominal hacia el tórax a través de un hiato esofágico diafragmático laxo. (En el 95% de los casos, una parte del estómago está herniada).
EPIDEMIOLOGÍA:
La incidencia aumenta con:
Edad: afecta a ∼ 70% de las personas > 70 años ↑ IMC (obesidad)
ETIOLOGÍA:
La etiología es multifactorial.
Hiato esofágico diafragmático laxo
Edad avanzada
Tabaquismo
Obesidad
Predisposición genética (rara)
CLASIFICACIÓN:
Períodos prolongados de aumento de la presión intraabdominal

Embarazo
Ascitis
Tos crónica
Estreñimiento crónico
Desplazamiento del segmento distal del esófago, de su localización abdominal normal a mediastino. Esta hernia puede incluir segmentos de estómago.
Tipo I: por deslizamiento. El más frecuente (95%) (ENARM 2006)
Tipo II: paraesofágica o por rodamiento
Tipo III: mixta, está formada por la combinación del tipo I y II. Asimismo, se
puede manifestar como una complicación de las dos anteriores.
Tipo IV: Hernia de cualquier estructura abdominal que no sea el estómago (Bazo, epiplón o colon), es el más raro.
Las complicaciones de los tipos II, III y IV suelen ser emergencias médicas (hemorragias digestivas altas) o quirúrgicas (perforación o vólvulo gástrico).
DIAGNÓSTICO:
La mayoría de los pacientes son asintomáticos.
Tipo I: síntomas de reflujo gastroesofágico (ERGE)
Tipo II, III y IV
♦ Dolor epigástrico / subesternal
♦ Saciedad precoz
♦ Náusea
♦ Se puede complicar con vólvulo gástrico (tipo II)
Esofagoscopía con bario: prueba más sensible, evalúa el tipo y tamaño de una hernia
Radiografía de tórax: Hallazgo generalmente incidental

Endoscopia: se utiliza para diagnosticar la hernia de hiato y evaluar posibles complicaciones.
Figura 59.
Tríada de Saint → colelitiasis, diverticulosis y hernia de hiato
Hernia hiatal Ingestión de bario, radiografía AP que muestra el esófago con contraste (1), el esfínter esofágico herniado (flecha), la hernia hiatal deslizante (2) y el estómago (3) con contorno típico.

TRATAMIENTO:
TIPO I:
Inicialmente médico para tratar ERGE
Cambios en los estilos de vida
IBP: omeprazol
Cirugía: funduplicatura laparoscópica (Nissen) / abierta e hiatoplastia, indicaciones:
♦ Persistencia de los síntomas a pesar del manejo médico
♦ Rechazo o incapacidad para tomar IBP a largo plazo
♦ Síntomas / complicaciones graves de la enfermedad por reflujo gastroesofágico: sangrado, estenosis, ulceraciones
TIPO II – III – IV:
Manejo conservador: pacientes mayores o con otras comorbilidades
Cirugía: herniotomía laparoscópica / abierta + funduplicatura
Asintomáticos, pequeñas hernias en pacientes < 50 años de edad Sintomático de tipo II, III, IV hernias
DEFINICIÓN:
Los divertículos esofágicos son bolsas anormales que surgen de la pared del esófago. El divertículo de Zenker es el más frecuente del esófago.
EPIDEMIOLOGÍA:
Ocurren con mayor frecuencia en hombres de mediana edad y ancianos.
PATOGENIA:
El divertículo de Zenker protruye a través del triángulo de Killian (formado por los músculos constrictores de la faringe y el músculo cricofaríngeo).
Asociado a hipertonía del músculo cricofaríngeo, que ante el aumento de la presión intraluminal, genera la protrusión de la mucosa y submucosa esofágica hacia la región posterior (Zenker es un divertículo falso formado por pulsión).

DIAGNÓSTICO:
Disfagia es el síntoma más común, halitosis, regurgitación constante y distrés respiratorio por neumonía por aspiración (principal complicación) (ENARM 2015)
Radiografía con contraste, mejor prueba de confirmación Se debe evitar estudios endoscópicos por posible lesión del divertículo (perforación)
TRATAMIENTO:
Tratamiento médico
IBP: para los síntomas del reflujo gastroesofágico
Inyección de toxina botulínica: en pacientes sintomáticos con trastornos de la motilidad esofágica y contraindicaciones para la cirugía.
Tratamiento quirúrgico
Indicaciones
Divertículos de Zenker sintomáticos
Asintomáticos > 1 cm
Puede realizarse manejo quirúrgico o endoscópico. Es importante, para evitar recidivas y tener mejores resultados incluir miotomía del músculo cricofaríngeo.


El tratamiento quirúrgico de las úlceras pépticas no complicadas rara vez es necesario porque suelen responder bien al tratamiento médico. Cuando se confirma la malignidad o se producen complicaciones como sangrado masivo o perforación gastrointestinal, se debe realizar una cirugía específica para estas complicaciones. (ESSALUD 2005)
Secciones parciales o totales de ramas del nervio vago. La denervación a través de la vagotomía total da como resultado una reducción de aproximadamente el 70% de la producción de ácido
Trayecto del nervio vago: a nivel de cardias se divide en una rama hepática y rama gástrica. La rama hepática se divide en ramas que inervan el píloro. La rama gástrica sigue su camino por la curvatura menor del estómago dando ramas parietales que inervan las células parietales. La rama gástrica termina dando origen al nervio de Latarjet formando la pata de ganso, se distribuye y termina finalmente en el antro gástrico. La formación de la pata de ganso se encuentra a 7 cm antes de llegar al píloro.
A: Troncal (suprahepática): Disección del nervio vago por encima de la bifurcación del nervio vago. Está indicada en neoplasias, gastrectomía totales y cirugías de emergencia. Asociado a antrectomía, tiene baja tasa de recidiva. (ESSALUD 2019)
B: Selectiva (infrahepática): Por debajo de la bifurcación del nervio vago. Mantiene indemne la rama hepática del nervio vago.
C: Supraselectiva o parietal: Disección únicamente de las ramas parietales. Inicia a 7 cm del píloro con el objetivo de evitar lesiones del nervio de Latarjet y pata de ganso.
En caso de úlceras perforadas se debe hacer rafia e incluir un parche de epiplon, conocido como “parche de Graham.” (ENARM 2021).
Retraso en el vaciamiento gástrico, diarrea posvagotomía, hipergastrinemia posvagotomía y síndrome de dumping.
Es el procedimiento quirúrgico que se realiza para extirpar todo el estómago (gastrectomía total) o parte de él (gastrectomía subtotal). La gastrectomía subtotal consiste en la disección solo del antro, segmento distal del estómago.
Tipos de Reconstrucción:
Billroth I: Anastomosis gastroduodenal término-terminal. Indicaciones: antrectomía por úlceras duodenales o antrales.
Billroth II: Anastomosis gastroyeyunal término-lateral. Indicado en neoplasias gástricas. Puede complicarse con síndrome de asa aferente y asa eferente (ENARM 2004)(ESSALUD 2003, 2018)




Y-Roux: es una cirugía complementaria a otras cirugías como prevención del síndrome de asa aferente.

Cirugía de Whipple: Duodenopancreatectomía cefálica. Indicado en cáncer de cabeza de páncreas.
Reflujo alcalino
Vaciamiento gástrico rápido (Síndrome de Dumping): en la fase temprana cursa con dolor, vómitos, deshidratación, diarrea, diaforesis y en fase tardía con hipoglicemia (ENARM 2017).
Anemia megaloblástica en resecciones extensas.

En el caso del manejo de la hipertensión portal tenemos las derivaciones portosistémicas:

La vena porta se deriva completamente a la vena cava, lo que reduce la presión portal. Las derivaciones portosistémicas totales reducen el riesgo de hemorragia varicosa (recurrente) y pueden reducir la ascitis existente. Sin embargo, como el hígado se pasa por alto de forma completa, existe un alto riesgo de encefalopatía.
Procedimiento: derivación porto cava.
La vena porta se deriva parcialmente a la vena cava, lo que reduce la presión portal. Esta derivación parcial previene las várices mientras continúa permitiendo la perfusión portal. Las derivaciones portosistémicas selectivas, por lo tanto, tienen un mayor riesgo de hemorragia varicosa recurrente, pero un riesgo menor de encefalopatía en comparación con las derivaciones portosistémicas totales.
Procedimiento: derivación espleno renal distal (técnica de Warren)(ESSALUD 2004)


Dos o más lesiones que ocurren en un mismo accidente y al menos una de ellas compromete la vida del paciente.
Evaluación primaria del politraumatizado – ABCDE (ENARM 2006, ENARM 2015, ENARM 2018) (ESSALUD 2003, 2010, 2015)
A. Asegurar la vía aérea y columna cervical mediante la colocación de collarín cervical. (ENARM 2000, ENARM 2006, ENARM 2010)

B. Respiración: Evaluación de la ventilación respiratorio
C. Circulación: Evaluar frecuencia cardiaca, pulso, llenado capilar y control de hemorragias importantes. Valorar estado de conciencia como signo indirecto de hipoperfusión (ENARM 2016).
D. Función neurológica: Valorar escala de Glasgow y reacción pupilar.
E. Examen físico general. Finalmente, cubrir al paciente para evitar hipotermia.
FAST: Estudio de ultrasonido que explora la zona perihepática, pericárdica, periesplénica, peripélvica en busca de la presión de líquido libre en cavidad abdominal (ENARM 2013).
Otros: amilasa > 175 UI, presencia de bilis, presencia de patógenos.
LPD (Lavado peritoneal diagnóstico): estudio más específico pero invasivo (ENARM 2015, ENARM 2018). Es positivo si: 10 ml de aspirado sanguíneo inicial > 100.000 eritrocitos o > 500 leucocitos por mm3
Si el examen FAST no está disponible, se debe llevar a un paciente hemodinámicamente inestable al quirófano de inmediato.
El examen radiológico más importante en la perforación de víscera hueca es la radiografía de abdomen simple en bipedestación teniendo como hallazgo neumoperitoneo, signo de las alas de gaviota si es bilateral, o signo de Popper si es unilateral.

(ESSALUD 2013)
VENTAJAS
Diagnóstico rápido
98% de sensibilidad
Detecta lesión intestinal
No requiere transporte
Invasivo
Baja especificidad
DESVENTAJAS
Diagnóstico rápido
Se puede repetir No invasivo
Alta sensibilidad
No requiere transporte
Operador dependiente
Distorsión con aire
No detecta lesión de diafragma o retroperitoneo

Estudio más específico
Alta sensibilidad
No invasivo
Costo y tiempo altos
INDICACIONES
T. contuso inestable
No detecta lesión de diafragma, intestino o páncreas
T. contuso inestable
Requiere transporte

Trauma estable
T. retroperit
Estabilidad hemodinámica
Ausencia de peritonitis
Ausencia de perforación
CIRUGÍA
Inestabilidad hemodinámica
Perforación
Peritonitis
Lesión por arma blanca: El órgano frecuentemente lesionado por arma blanca es el hígado, seguido por intestino delgado y diafragma. La mayoría de los estudios indican que el traumatismo abdominal cerrado es más común que las heridas por arma blanca y que las heridas por arma blanca son más frecuentes que las heridas por arma de fuego en la población civil.
Lesión por arma de fuego: El órgano frecuentemente lesionado por arma de fuego es el intestino delgado, seguido por el colon e hígado. Las heridas de bala abdominales, debido a su mayor energía cinética, se asocian con tasas de mortalidad aproximadamente ocho veces más altas que las heridas de arma blanca abdominales
EVALUACIÓN
Lesión por arma blanca: La duración requerida de la observación después de una puñalada en el abdomen que penetra en la fascia del recto anterior es de al menos 12 horas. Los pacientes de las siguientes categorías deben ser observados durante al menos 24 horas:
♦ Mayores de 65 años
♦ Tomar anticoagulantes o medicamentos antiplaquetarios en el momento de la lesión.
♦ Tienen comorbilidades médicas importantes que pueden afectar la detección de lesiones internas (p. Ej., Diabetes)

♦ Tiene otras lesiones importantes que justifiquen la observación.
Los pacientes sin indicaciones aparentes de laparotomía pueden ser evaluados mediante una o más de las siguientes técnicas:
♦ Exploración local de heridas (evaluar su profundidad y trayecto)
♦ Radiografía simple
♦ Tomografía computarizada (ENARM 2019)
♦ Exámenes físicos seriados
Lesión por arma de fuego: se clasifican en tres tipos según la distancia:
♦ Las heridas de tipo I (> 6,4 m; > 7 yardas) se limitan típicamente al tejido subcutáneo y las capas fasciales profundas.
♦ Las heridas de tipo II (2.7 a 6.4 m; 3 a 7 yardas) ocurren cuando los proyectiles ingresan a la cavidad abdominal debido a una dispersión más apretada del perdigón y al aumento de la velocidad.
♦ Las heridas de tipo III (< 2,7 m; < 3 yardas) provocan una pérdida y destrucción masiva de tejido, además de los contaminantes añadidos de los escombros.
La mayoría de las heridas por bala son letales cuando ocurren a corta distancia (<2,7 m; <3 yardas).
Lesión por arma blanca:
Debe evaluarse inicialmente la estabilidad hemodinámica, en caso de inestabilidad hemodinámica, peritonitis, sangre franca de una sonda nasogástrica o en el tacto rectal, la evisceración de órganos intraabdominales o epiplón → corresponde una exploración quirúrgica inmediata (laparotomía). Los antibióticos de amplio espectro generalmente se administran a pacientes con lesión abdominal penetrante que requiere tratamiento quirúrgico, pero por lo demás no se administran.
En caso de estabilidad hemodinámica, corresponde explorar la lesión en busca de posible perforación a la cavidad abdominal.
Lesión por arma de fuego: son usualmente de conducta quirúrgica, a menos que el paciente se encuentre hemodinámicamente estable y la bala o perdigón no haya penetrado la cavidad abdominal, caso común en las lesiones tangenciales. Las indicaciones para la laparotomía inmediata incluyen lo siguiente

♦ Signos de hemorragia abdominal: hipotensión, taquicardia, cianosis, ansiedad, decoloración del flanco, shock (inestabilidad hemodinámica)
♦ Dolor, rigidez abdominal y distensión (signos de peritonitis)
♦ Evisceración del contenido abdominal (intestino o epiplón)
♦ Hematemesis o sangre macroscópica por recto
♦ Síndrome compartimental abdominal.
Por lo general, se administran antibióticos de amplio espectro a pacientes con lesión abdominal penetrante que requiere tratamiento quirúrgico

Figura 71 . Algoritmo sugerido de manejo del trauma abdominal abierto
TRAUMA ABDOMINAL CERRADO (ENARM 2014, ENARM 2015, ENARM 2011, ENARM 2018, ENARM 2019)
El órgano frecuentemente lesionado por trauma cerrado es el bazo, seguido del hígado (ENARM 2017)(ESSALUD 2003, 2014).
El traumatismo abdominal cerrado representa la mayoría (80 %) de las lesiones abdominales atendidas en el Departamento de Urgencias. La mayoría de los casos están relacionados con:
♦ Accidentes automovilísticos (75 %)
♦ Los golpes en el abdomen (15%)
♦ Las caídas (6 al 9 %)
En casos de trauma abdominal cerrado lo primero a evaluarse son las funciones vitales, presión arterial y frecuencia cardiaca.
Los hallazgos del examen físico y laboratorio más fuertemente asociados con la lesión intraabdominal son los siguientes:
Signo del cinturón de seguridad
Sensibilidad de rebote o blumberg (+)
Hipotensión (definida como presión arterial sistólica (PAS) <90 mmHg)
Distensión y resistencia abdominal
Fractura concomitante de fémur
La lesión esplénica asociada con sangre adyacente al hemidiafragma izquierdo puede causar dolor referido en el hombro izquierdo (signo de Kehr)
Un hematocrito por debajo del 30 % La lesión hepática se asocia con elevaciones en las concentraciones de transaminasas
La hematuria macroscópica sugiere una lesión renal grave
Los hallazgos en la radiografía de tórax que sugieren una lesión intraabdominal incluyen:
Fracturas de costillas inferiores
Hernia de diafragma

Aire libre debajo del diafragma (neumoperitoneo)
El estudio del paciente con trauma abdominal cerrado e inestabilidad hemodinámica debe realizarse con FAST o lavado peritoneal diagnóstico (ESSALUD 2006)

En caso de estabilidad hemodinámica el paciente queda en observación y se puede valorar posibles lesiones con tomografía.

En caso de inestabilidad hemodinámica, la prioridad es compensarlo reponiendo volumen con cristaloides. El hallazgo positivo en FAST o lavado peritoneal diagnóstico es indicación de laparotomía exploradora, siempre correlacionando con la clínica del paciente.
Indicaciones clínicas para la laparotomía:
♦ Signos inexplicables de pérdida de sangre o hipotensión en un paciente que no se puede estabilizar y en el que se sospecha fuertemente una lesión intraabdominal.
♦ Signos claros y persistentes de irritación peritoneal.
♦ Evidencia radiológica de neumoperitoneo compatible con ruptura de víscera
♦ Evidencia de una rotura diafragmática
♦ Hemorragia gastrointestinal significativa y persistente observada en el drenaje nasogástrico o en el vómito.
Concepto quirúrgico orientado a priorizar el control del sangrado y control de la contaminación en un paciente en muy mal estado general, usualmente aquel que cumple los criterios de la “triada letal” (ESSALUD 2018) (ENARM 2021): hipotermia, coagulopatía y acidosis metabólica. La cirugía de control de daños está orientada a resolver el trauma en tres etapas:
Primera etapa: cirugía de emergencia, de corta duración, en el que solo se realiza hemostasia y se realizan medidas para evitar la contaminación. No se realizan reparaciones ni anastomosis.
(ESSALUD 2010, 2018)
Segunda etapa. El paciente pasa a cuidados críticos para ser estabilizado.
Tercera etapa: Se realiza la cirugía correctiva, que incluye reparaciones y anastomosis.






Hematoma < 10% de la superficie - Laceración < 1 cm
Hematoma 15-50% de la superficie - Laceración 1-3 cm (ENARM 2021)
Hematoma >50% de la superficie - Laceración > 3 cm
Hematoma roto - Laceración < 50 %
Laceración > 50 %
Avulsión
La indicación quirúrgica del trauma hepático depende de la correlación entre el estado clínico del paciente y la severidad de a lesión. En el manejo del trauma hepático se pueden considerar las siguientes maniobras.

Maniobra de Pringle: Consiste en la oclusión del ligamento hepatoduodenal que contiene al triado portal (arteria, vena, conducto biliar) con la finalidad de favorecer la hemostasia por un período de 30 minutos como máximo (ENARM 2013, ENARM 2015).

Control de daños: Mediante el packing hepático o taponamiento hepático. El objetivo es disminuir el sangrado y el riesgo de contaminación. Puede considerarse un tiempo aproximado de 12 horas a 7 días, siendo 48 a 72 horas el tiempo promedio.(ESSALUD 2001)

Clasificación del trauma esplénico
Hematoma < 10% de la superficieLaceración < 1 cm
Hematoma 15-50% de la superficieLaceración 1-3 cm
Hematoma >50% de la superficieLaceración > 3 cm
Hematoma roto - Laceración < 50 % Laceración > 50 % o avulsión esplénica
Clasificación del trauma intestinal
Hematomas - Laceración superficial
Laceración < 50%

Laceración > 50%
Laceración total
Lesión vascular
En el manejo del trauma intestinal, el grado I se puede rafiar la laceración. El grado II y III incluye debridación de bordes y rafia de la laceración. El grado IV y V incluye resección de segmento intestinal y anastomosis. La posibilidad de colostomía depende de criterios generales que incluyen el estado nutricional y estado general del paciente.

El trauma renal es ocasionado principalmente por accidentes de tránsito (traumatismo abdominal cerrado en el 80% de los casos), usualmente asociado a fracturas costales inferiores (9 º -12 º), menos común por traumatismo penetrante (heridas de bala o arma blanca). (ENARM 2022)
Escala de daño renal de la AAST
1 Contusión o hematoma subcapsular no expansivo. No laceración
2 Hematoma perirrenal delimitado o laceración cortical renal que penetra < 1cm en profundidad sin extravasación urinaria.
3 Laceración cortical > 1 cm sin extravasación urinaria.
4 Laceración renal con extravasación urinaria o afectación arterial o venosa con hematoma contenido.
5 Riñón completamente destrozado o afectación importante del pedículo con avulsión del hilio que desvasculariza el riñón.
Debe sospecharse cuando el politraumatizado presenta dolor en el lado afectado asociado a hematuria en el examen de orina.
Para confirmar un trauma renal debe realizarse una tomografia (UroTEM con contraste).
Análisis de orina: hematuria macroscópica o hematuria microscópica
♦ El color de la orina no se correlaciona con la gravedad de la lesión
El manejo del trauma renal depende principalmente de la correlación clínica y severidad de la lesión.





Lesión renal de bajo grado
♦ Observación y monitorización de constantes vitales con reposo en cama

♦ Profilaxis antibiótica
♦ Monitorear la hematuria
Se considera de exploración quirúrgica, aquellos pacientes con lesión grado V, o con lesiones menores asociadas a inestabilidad hemodinámica sin otro foco demostrado. Asimismo, los pacientes monorrenos son de indicación quirúrgica.
Las lesiones de uréter pueden ocurrir en el contexto de un accidente, trauma abdominal cerrado, o incluso un procedimiento quirúrgico iatrogénico, como las histerectomías.
Pueden cursar asintomáticos inicialmente, sin embargo, se debe sospechar lesión de uréter en aquellos casos en los que se presente hematuria microscópica al examen de orina. La confirmación de la lesión puede realizarse con urografía excretora.
GRADO LESIÓN
I Hematoma periureteral
II Laceración <50% de circunferencia ureteral

III Laceración >50% circunferencia ureteral
IV Sección completa <2 cm devascularización
V Sección completa > 2cm devascularización
De confirmarse una lesión ureteral, el procedimiento inicial es realizar una derivación de la orina proximal a la lesión, por lo que se prefiere realizar nefrostomía para desfuncionalizar uréter. Luego de acuerdo a la severidad de la lesión, se puede considerar distintos tipos de reconstrucción, anastomosis o colgajos.
La vejiga, anatómicamente tiene una porción peritoneal (o intraperitoneal), correspondiente al polo superior y posterior principalmente, así como una porción extraperitoneal, principalmente la región anterior.
La vejiga se lesiona con más frecuencia en el contexto de una fractura de pubis (porción extraperitoneal), pero puede estar relacionado a trauma abdominal cerrado o incluso por arma de fuego.
Se debe sospechar de trauma vesical cuando el paciente presenta hematuria macroscópica asociado a dolor en la parte inferior del abdomen. Lesión intraperitoneal: irritación peritoneal y ↑ creatinina sérica.
La confirmación se realiza con una cistografía retrógrada, la cual identificará la zona de lesión.
I Hematoma Contusión, hematoma intramural
I Laceración Grosor parcial
II Laceración Extraperitoneal < 2cm de la pared vesical
III Laceración Extraperitoneal (>2cm) o extraperitoneal (<2cm)
IV Laceración Intraperitoneal > 2 cm de la pared vesical
V Laceración Intra o extra que compromete cuello trígono
De confirmarse un trauma vesical, la conducta inicial es evacuar la orina, con una sonda vesical (Foley) siempre en cuando se descarte una lesión uretral. El tratamiento definitivo dependerá de la zona de lesión:

Lesión extraperitoneal:
< 2cm: conducta expectante, puede resolverse espontáneamente.
> 2cm: debe repararse quirúrgicamente.

Lesión intraperitoneal:
Debe explorarse quirúrgicamente.
En pacientes con fracturas pélvicas, siempre evalúe la posible lesión del sistema genitourinario.
Casi exclusivamente visto en hombres (menos común en mujeres debido a una uretra más corta y móvil)
La uretra puede lesionarse en sus porciones anterior o posterior.
La anterior usualmente por caídas con lesiones perineales,
como la caída “a horcajadas”. la uretra bulbar es la más comúnmente lesionada.
La uretra posterior, que es la más frecuentemente lesionada ocurre principalmente en el contexto de accidentes de tránsito que incluyan fractura de pelvis a nivel del pubis. la unión bulbomembranosa suele lesionarse.


La manifestación clínica más importante de la lesión de uretra es la uretrorragia, o sangrado por vía uretral, asociado a imposibilidad para la micción, pudiendo presentar globo vesical, inclusive.
Algunas lesiones, pueden presentar el signo de alas de mariposa (uretra anterior), que es un hematoma característico en la zona perineal.
Próstata alta en el examen (uretra posterior)
Para confirmar un trauma de uretra debe realizarse una uretrografía retrógrada con contraste (ENARM 2019). Hallazgos: extravasación de contraste de la uretra en el punto de la lesión.
♦ Si algo de contraste entra en la vejiga → lesión parcial
♦ Si no entra contraste en la vejiga → lesión completa
♦ La rotura completa de la uretra es más probable en la lesión de la uretra posterior.
Ante el hallazgo de una lesión de uretra debe realizarse una talla vesical (citostomía) para evacuar la vejiga.
Está contraindicado la colocación de sonda Foley (cateterismo vesical), que pudiera agravar la lesión.
La reparación dependerá del grado de lesión.

♦ Lesión uretral anterior
♦ Lesión parcial: coloque el catéter de Foley para que cicatrice por segunda intención
♦ Lesión total: exploración quirúrgica con desbridamiento y reparación del defecto con anastomosis directa sobre catéter
♦ Lesión uretral posterior
♦ Abordaje endoscópico: realineamiento temprano (dentro de 1 semana) con abordaje combinado transuretral y transvesical percutáneo
♦ Abordaje quirúrgico: colocar catéter suprapúbico → uretroplastia retardada (6 a 12 semanas después de la lesión inicial
Los más frecuentes son los leiomiomas submucosos. (ESSALUD 2015) Generalmente son asintomáticos, los pacientes sintomáticos refieren disfagia progresiva. Es común la presencia de síntomas en tumores mayores de 5 cm. El tratamiento quirúrgico está indicado solo en casos sintomáticos.
Sexo: ♂ > ♀ (3: 1)
La mediana de edad de inicio: entre 60 y 70 años de edad
Adenocarcinoma: el tipo más común de cáncer de esófago en tercio inferior.
Carcinoma epidermoide: el tipo de cáncer de esófago más común en tercio medio.

Adenocarcinoma
Fumador (riesgo doble)
Obesidad
Sexo masculino
Edad avanzada (50 a 60 años)
Reflujo gastroesofágico
Esófago de Barrett (+ importante)
Localización: principalmente en el tercio inferior del esófago
Carcinoma epidermoide
Alcoholismo (+ importante)
Tabaquismo (riesgo nueve veces mayor, + importante)
Dieta baja en frutas y verduras
Bebidas calientes
Exposición a nitrosaminas (Embutidos, pescado, tocino)
Estenosis cáusticas
VPH
Radioterapia
Candidiasis esofágica
Sexo masculino
Edad avanzada (60 a 70 años)
Ascendencia afroamericana
Pérdida de peso
Signos de anemia
Disfagia progresiva (de sólidos a líquidos) con posible odinofagia (ENARM 2021)
Adenopatía cervical
Ronquera y / o tos persistente
Síndrome de horner (miosis + ptosis + enoftalmos)
Signos de hemorragia digestiva alta (hematemesis + melena)
Endoscopía:
Mejor prueba inicial y confirmatoria
Permite la biopsia de cualquier lesión sospechosa.
TAC de tórax y abdomen
Identificar la ubicación y el contenido de la lesión y excluir metástasis a distancia.
TRATAMIENTO
Curativo
Indicación: Enfermedad localmente invasiva que no ha invadido las estructuras circundantes.
Métodos: Resección quirúrgica
♦ Resección endoscópica submucosa para la eliminación de lesiones epiteliales superficiales
♦ Esofagectomía subtotal o total
Síndrome de Plummer-Vinson
Acalasia
Divertículos (Divertículo de Zenker )
Tilosis
Localización: principalmente en los dos tercios superiores del esófago
En caso de que la tomografía computarizada no muestre enfermedad metastásica, se puede agregar una tomografía por emisión de positrones para aumentar la precisión del diagnóstico.
Ecografía endoscópica transesofágica
Se utiliza para determinar la profundidad de infiltración y registrar la enfermedad de los ganglios linfáticos regionales.
Broncoscopia
Para la estadificación de las lesiones en la carina o por encima de ella para descartar la afectación de las vías respiratorias (bronquio izquierdo se relaciona con el esófago)
Paliativo
Indicación: pacientes con enfermedad avanzada (mayoría de pacientes)
Métodos
♦ Quimiorradiación
♦ Colocación de stent
♦ Otros tratamientos endoscópicos (Terapia con láser)
LOCALIZACIÓN TIPO CARACTERÍSTICAS TRATAMIENTO
⅓ superior Carcinoma epidermoide
⅓ medio (más frecuente)

⅓ inferior Adenocarcinomas
Diseminación por contigüidad.
Factores de riesgo: Tabaco y alcohol (ENARM 2019)
Diseminación vía hematógena al hígado por vena porta.
Factores de riesgo: Esofagitis de Barret, tabaco
Esofaguectomía radical
Esofaguectomía + gastrectomía
Los tumores benignos más frecuentes son los pólipos (ENARM 2011, ENARM 2002). Asimismo hay presencia importante de leiomiomas y otros, sin consideraciones clínicas muy trascendentes.
Hiperplásicos: es el más común, de bajo riesgo de malignización.
Adenomatosos: tienen alto riesgo de malignización, sobre todo si son >2 cm o están asociados a síndromes neoplásicos hereditarios. Tiene indicación quirúrgica. (ESSALUD 2018)
Hamartomas: Asociado a otros síndromes (Ej, síndrome de Peutz-Jeghers) (ENARM 2004).
El más frecuente es el adenocarcinoma (ENARM 2010) (ESSALUD 2005).
♦ Representa ∼ 95% de los casos
♦ Más comúnmente se encuentra en la curvatura menor
♦ Surge de las células glandulares del estómago
Es común en varones mayores de 60 años.
Se localizan con más frecuencia en la región antral (ENARM 2009) (ESSALUD 2005)
La lesión premaligna más frecuente es la gastritis crónica atrófica. Asimismo, se asocia a sindromes polipósicos, anemia perniciosa y otros.


Antecedentes familiares y/o personales, grupo sangruíneo tipo A, Helicobacter pylori (+ importante), dieta rica en sales o nitratos (Alimentos secos, alimentos conservados o ahumados), anemia perniciosa o gastritis crónica atrófica, úlceras gástricas, pólipos adenomatosos, aclorhidria (Debido a la enfermedad de Ménétrier ) (ENARM 2010, ENARM 2018) (ESSALUD 2004, 2005, 2015)
Dieta, AINES (usados como estimuladores de la apoptosis, en casos de lesiones con alto riesgo de malignización)
Clínica:

El cuadro clínico es inespecífico, el paciente puede referir llenura precoz, dolor abdominal, palpación de masa en epigastrio y baja de peso. Los signos que sugieren diseminación son la presencia de ganglios en diferentes zonas.
Ganglio de Virchow o supraclavicular izquierdo
Ganglio de Irish o axilar
Síndromes paraneoplásicos
Ganglio de María José o periumbilical Tumor de Krukenberg, que incluye diseminación a anexos (ovarios).
Signo de Leser-Trélat: que se manifiesta como múltiples queratosis seborreicas de aparición repentina.
Acantosis nigricans maligna: Se presenta como lesiones cutáneas verrugosas o papulosas, hiperpigmentadas, pruriginosas y de rápido crecimiento. Afecta principalmente al cuello, zona genital y axilas.


Enfermedad metastásica
Invasión local de estructuras adyacentes
♦ Carcinomatosis peritoneal
♦ Infiltración de estructuras como el esófago, el colon transverso y el páncreas
Propagación hematógena
♦ Esqueleto
♦ Hígado
♦ Pulmón
♦ Cerebro
Exámenes:
El estudio de elección es la endoscopia con toma de biopsia.



Para realizar estadiaje es necesario identificar el TNM adecuadamente por lo que se debe realizar ecoendoscopía, de mayor sensibilidad para identificar penetración en la pared.
La tomografía es el estudio de elección para evaluar metástasis a distancia (ENARM 2017, ENARM 2020).

Son útiles también los estudios radiográficos a doble contraste pero sin superar a los descritos previamente.


Clasificación de Borrmann: Indicado para cáncer avanzado (ENARM 2005) Se define como aquel que ha invadido la capa muscular de la pared gástrica.
♦ I → Lesión polipoide elevada (ENARM 2021)
♦ II → Úlcera con bordes elevados
♦ III → Lesión ulcerada con infiltraciones
♦ IV → Lesión por infiltración y diseminación por continuidad (linitis plástica)

Clasificación Japonesa para cáncer temprano: Indicado para cáncer temprano (early cáncer), no llega a la capa muscular.
0-I → lesión elevada
0-IIa → lesiones superficiales elevada
0-IIb → lesiones superficiales planas

0-IIIc →lesiones superficiales erosionada



0-III → lesión ulcerada




Clasificación de Lauren:
Intestinales → Alto grado de diferenciación. Asociados a la gastritis crónica atrófica. Difusos → Bajo grado de diferenciación. Asociado a factores genéticos y hereditarios como el grupo sanguíneo A. Presencia de células en anillo. De peor pronóstico.
Mixtos
Clasificación TNM: se emplea para determinar el grado de extensión de la enfermedad (ENARM 2007).
Tumor primario (T)
TX No se puede evaluar el tumor primario
T0 No hay evidencia de tumor primario
Tis Carcinoma in situ: Tumor intraepitelial sin invasión de lámina propia
T1 Invade la lámina propia, la muscularis mucosae, o la submucosa
T1a Invade la lámina propia o la muscularis mucosae
T1b El tumor invade la submucosa
T2 El tumor invade la capa muscular propia
T3 Invade subserosa sin invasión de serosa ni estructuras adyacentes
T4 Penetra la serosa (peritoneo visceral) o estructuras adyacentes
T4a Penetra la serosa (peritoneo visceral)
T4b Invade estructuras adyacentes
Ganglios linfáticos regionales (N)
NX No se pueden evaluar el/los ganglio(s) linfático(s) regionales
N0 No se evidencia metástasis a ganglios linfáticos regionales
N1 Metástasis en 1 a 2 ganglios linfáticos regionales
N2 Metástasis en 3 a 6 ganglios linfáticos regionales
N3 Metástasis en más de 7 ganglios linfáticos regionales
N3a Metástasis en 7 a 15 ganglios linfáticos regionales
N3b Metástasis en 16 a más ganglios linfáticos regionales
Met dist (M) M0 No metástasis a distancia
M1 Metástasis a distancia

Es quirúrgico y depende de la localización de la neoplasia. Se incluye quimioterapia coadyuvante.

Trastuzumab está indicado para adenocarcinomas gástricos positivos para HER2
En casos de tumores resecables las opciones son:
♦ Neoplasia a nivel del antro: gastrectomía subtotal (ENARM 2021), más reconstrucción tipo Billroth II, más disección ganglionar amplia (D2) más quimioterapia coadyuvante. (ESSALUD 2003, 2013)
♦ Neoplasia a nivel del cuerpo o fondo: gastrectomía total (GT)que puede incluir esofaguectomía.
Debido a que no hay signos tempranos, el cáncer gástrico a menudo se diagnostica muy tarde. Alrededor del 50% de los cánceres ya han alcanzado una etapa avanzada que no permite un tratamiento curativo debido a la invasión tisular y las metástasis.
Si se diagnostica en una etapa muy temprana, la tasa de supervivencia a 5 años es del 95%.
La enfermedad en estadio tardío con metástasis a distancia y / o carcinomatosis peritoneal tiene un pronóstico sombrío (tasa de supervivencia a cinco años de ~ 5% )
Los linfomas son de tipo MALT (Tumor de tejido linfoide asociado a mucosas), asociado a infección crónica por Helicobacter pylori.
Corresponde a la localización extraganglionar más frecuente de los linfomas no Hodking (ENARM 2021)
El tratamiento es principalmente quimioterapia, sin embargo, se debe considerar la cirugía en aquellos casos recurrentes o que no remitan con qumioterapia.
El pólipo adenomatoso es el más frecuente. La localización de pólipos en el aparato digestivo es más común a nivel del colon (ENARM 2014). Tienen a malignizar cuando son >2 cm, son múltiple s o están asociados a componente hereditario (poliposis adenomatosa familiar).
Tipos histológicos (ENARM 2005):
Tubulares
Vellosos: mayor riesgo de malignización. Son muy secretores, generan diarreas severas y alteraciones electrolíticas. Pueden presentar sangrado.
Tubulovellosos
Poliposis adenomatosa familiar (PAF) o poliposis colónica familiar: es un síndrome hereditario y suele aparecer asociado al síndrome de Gardner. Existen dos tipos:
Clásica: presencia > 100 pólipos en la colonoscopía.
Atenuada: presencia < 100 pólipos en la colonoscopía
En ambos tipos se debe evaluar la mutación del gen APC, si hay presencia del gen se indica colonoscopía anual hasta que se hallen los pólipos. Una vez localizados se indica colectomía total.
El más frecuente es el adenocarcinoma.
La incidencia aumenta a partir de los 50 años. Comúnmente se localiza en el colon izquierdo.
Vía de la inestabilidad cromosómica en cáncer de colon: La secuencia adenoma -carcinoma es la acumulación progresiva de mutaciones en oncogenes (por ejemplo, KRAS ) y genes supresores de tumores (por ejemplo, APC , TP53 ) que da como resultado la lenta transformación de adenomas en carcinomas.
♦ Mutación del gen APC (pérdida de adhesión celular y aumento de la proliferación celular)
La lesión precancerígena más importante es el pólipo adenomatoso, lesión más comúnmente implicada en la historia natural del cáncer colorrectal.
→ Mutación del gen KRAS (señalización celular no regulada y proliferación celular) → Mutación del gen TP53
♦ La mayoría de los casos de colorrectal esporádico se desarrollan a través de esta vía.
Sobreexpresión de COX-2
♦ Asociado con cáncer colorrectal
♦ Posible efecto protector del uso prolongado de aspirina y otros AINE
Edad > 40 años, síndromes hereditarios (poliposis adenomatosa familiar, síndrome de Gardner, síndrome de Turcot, síndrome de Peutz-Jeghers, síndrome de poliposis juvenil), obesidad, dieta alto en grasas o carnes procesadas, hábitos nocivos (tabaco, alcohol), procesos inflamatorios crónicos como enfermedad de Crohn, colitis ulcerosa de varios años de evolución (ENARM 2006) (ESSALUD 2019).
Dieta alta en fibras, AAS (aspirina), calcio, actividad física.
La anemia por deficiencia de hierro en hombres > 50 años y mujeres posmenopáusicas debe suscitar sospechas de cáncer colorrectal.
Normalmente, los cánceres de colon y recto superior inicialmente hacen metástasis en el hígado a través de la vena porta, y los cánceres de recto inferior inicialmente hacen metástasis en el pulmón a través de la vena cava inferior.
Clínica:

Las manifestaciones clínicas dependen de la localización del carcinoma.
Carcinomas del lado izquierdo: Tienen crecimiento anular estenosante por lo que pueden presentar principalmente obstrucción intestinal, cambios en los hábitos intestinales (tamaño, consistencia, frecuencia)(ESSALUD 2013, 2019)

Carcinomas del lado derecho: De crecimiento vegetativo por lo que presentan principalmente sangrado microscópico o melena, manifestándose con anemia ferropénica (ENARM 2007, ENARM 2013) (ESSALUD 2009).
Enfermedad metastásica:
Metástasis hepáticas (ENARM 2021)
Metástasis pulmonares
Metástasis linfáticas
Metástasis peritoneales
Exámenes:
Radiografía abdominal con contraste: Signo de la manzana mordida. El estudio más importante en el diagnóstico es colonoscopía con toma de biopsia (ENARM 2015).

TAC en busca de diseminación y metástasis a distancia. (ESSALUD 2007)
Marcador tumoral: CEA (antígeno carcinoembrionario): tiene mayor utilidad en el seguimiento postoperatorio (ENARM 2003, ENARM 2011, ENARM 2021).
CEA es un marcador de pronóstico y no debe usarse para detectar cáncer colorrectal.
Tamizaje
Incluye la colonoscopía y el test de Thevenon en heces.
En pacientes sin factores de riesgo se debe iniciar a los 50 años y se repite cada 10 años (ENARM 2020).
En pacientes con factores de riesgo se debe iniciar a los 40 años y se repite cada 5 años
T0 No hay evidencia de tumor primario
Tis Carcinoma in situ: Tumor intraepitelial o invasión de la lámina propia
T1 Invade la submucosa
T2 Invade la capa muscular propia
T3 Invade capa muscular propia hasta capa subserosa o tej pericolorrectales no peritonizados
T4 Penetra la serosa (peritoneo visceral) o estructuras adyacentes
T4a Penetra la serosa (peritoneo visceral)
T4b Invade estructuras adyacentes
NX No se pueden evaluar el/los ganglio(s) linfático(s) regionales
N0 No se evidencia metástasis a ganglios linfáticos regionales
N1 Metástasis en 1 a 3 ganglios linfáticos regionales
N1a Metástasis en 1 ganglio linfático regional
N1b Metástasis en 2 – 3 ganglios linfáticos regionales
N1c Se evidencian nódulos de células tumorales en la subserosa, mesenterio o tejidos pericolorrectales no peritonizados sin evidencia de metástasis a ganglios linfáticos reg
N2 Metástasis en 4 a más ganglios linfáticos regionales
N2a Metástasis en 4 a 6 ganglios linfáticos regionales
N2b Metástasis en 7 a más ganglios linfáticos regionales
Tabla 10. Clasificación TNM
ESTADIAJE DUKES DESCRIPCION
T1N0M0 A Limitado a la mucosa
T2N0M0 B1 Limitado a la muscular propia
T3N0MO B2 Extensión transmural
T2N1M0 C1 T2, invade nódulos mesentéricos
T3N1M0 C2 T3, invade nódulos mesentéricos
T4 C2 Invasión de órganos adyacentes
Cualquier T, M1 D Metástasis a distancia
Tabla 11. Clasificación de Dukes
El tratamiento del cáncer de colon es principalmente quirúrgico, complementado con quimioterapia. La radioterapia no es una modalidad terapéutica estándar para los cánceres de colon.
Hemicolectomía izquierda o derecha dependiendo de la zona del tumor (ENARM 2021)
En caso se hallen en los ángulos (hepático o esplénico) se realizará hemicolectomía ampliada o extendida (ENARM 2019).
Colectomía total: indicada en tumores múltiples, PAF.
Tasa de supervivencia a cinco años
- Enfermedad localizada: 90%

- Diferencial regional: 72%
- Metástasis a distancia: 14%
- Todas las etapas combinadas: 65%
GENERALIDADES
El adenocarcinoma es el más frecuente, al igual en el resto del colon, usualmente precedido por un pólipo .
Neoplasias malignas del intestino grueso ubicadas a ≤ 15 cm del borde anal
Se pueden dividir en:
♦ Cáncer de recto superior: la diseminación es por vía hepática (ESSALUD 2015)
♦ Cáncer de recto inferior: la diseminación es por vía extrahepática.
DIAGNÓSTICO
Clínica:
Sangrado rectal o hematoquezia. Flatulencia o incontinencia fecal.
Obstrucción intestinal en casos avanzados.
TRATAMIENTO:
Exámenes: Rectoscopía con toma de biopsia (ESSALUD 2003)
Cirugía resectiva más quimioterapia neoadyuvante, el tipo de vía quirúrgica depende de la ubicación.
En casos de cáncer de recto inferior se prefiere cirugía abdomino-perineal (ESSALUD 2015)
GENERALIDADES
El más frecuente es el carcinoma epidermoide (ENARM 2017).
FACTOR DE RIESGO
Infección por VPH 16/18 (ENARM 2003)
Inmunodeficiencia (p. Ej., VIH )
Más común trabajadores sexuales, varones homosexuales.
DIAGNÓSTICO
Clínica
Sangrado rectal (síntoma inicial más importante)
Un bulto o tumor alrededor del ano.
Prurito anal
Sensibilidad, dolor en la zona anal.
Incontinencia fecal
Historia de condiloma anorrectal
TRATAMIENTO:
Asociado a conductas de riesgo (coito anal receptivo)
Tabaquismo
Metástasis
♦ Invasión local de órganos adyacentes
♦ Diseminación linfática (30% de los pacientes): perirrectal, paravertebral, inguinal, femoral
♦ Diseminación hematógena (<10% de los pacientes): hígado, hueso, pulmón
Quimioterapia más radioterapia combinadas (ENARM 2003, ENARM 2006)
Si fracasan se opta por cirugía, que consiste en resección abdominoperineal.
El más frecuente es el mucocele.
El tumor carcinoide es la primera causa seguido del adenocarcinoma. (ESSALUD 2003)
DIAGNÓSTICO:
Usualmente incidental mediante el estudio anatomopatológico de a apendicitis aguda. Los casos sintomáticos han cursado previamente con síndrome carcinoide.
TRATAMIENTO:
Dependerá del tipo histológico
Tumor carcinoide:
< 2 cm de diámetro sin invasión de base apendicular o de mesenterio → apendicectomía.
≥ 2 cm de diámetro con compromiso de base, mesenterio o ganglios linfáticos → hemicolectomía del lado derecho (ENARM 2017) (ESSALUD 2019).
Adenocarcinoma: Debido a su mayor agresividad, hemicolectomía del lado derecho. Luego del tratamiento quirúrgico se debe hacer el seguimiento con marcadores, principalmente el 5-HIAA (ácido 5-hidroxindolacético).
Tumor carcinoide
Es de secreción neuroendocrina, se puede localizar en cualquier parte del tubo digestivo, sin embargo, es más frecuente en el intestino delgado (ileon), seguido del recto y apéndice (ENARM 2003, ENARM 2006, ENARM 2021)(ESSALUD 2003, 2008). Tienden a secretar serotonina, triptófanos y prostaglandinas. El tumor carcinoide clásico, proveniente del intestino primitivo medio es secretor de serotonina.
En las fases iniciales aparece rubor facial acompañado de cianosis aparente, en fases tardías aparece el síndrome carcinoide clásico (taquicardia, broncoespasmo, vómitos, diarreas, dolor abdominal, falla cardiaca derecha, valvulopatía tricúspidea) (ENARM 2007) (ESSALUD 2003).
Medición de 5-HIAA en orina, TAC y biopsia (ENARM 2005).
Los más frecuentes son los adenocarcinomas de la vía biliar principal. Son más frecuentes los de localización extrahepática proximal (perihiliar).
Estos son clasificados por Bismuth, de
los cuales el tipo II es el más común, y corresponde al tumor de Klatskin, de localización en la confluencia de los conductos hepáticos izquierdo y derecho.
(ESSALUD 2011, 2016)
Colangitis esclerosante primaria, parasitosis como fasciolasis, quiste de colédoco, hepatitis viral crónica (VHB, VHC) y otros.
Clínica (ESSALUD 2019):
Los más comunes, correspondientes a los proximales, cursan principalmente con signos y síntomas de colestasis (ictericia, acolia, coluria, prurito). No dilatan la vía biliar en fases iniciales.

Los colangiocarcinomas distales sí pueden generar dilatación vesicular (Signo de Courvoisier) y manifestaciones similares al del cáncer de cabeza de páncreas u otros tumores periampulares.
Imágenes:
La colangiografía es el estudio de elección, pudiendo realizarse por vía endoscópica o por colangiorresonancia magnética. (ESSALUD 2019)
Marcadores tumorales (para determinar la línea de base; no deben usarse para confirmar el diagnóstico)
↑ AFP, ↑ CA 19-9 y ↑ CEA
Depende de la localización de la neoplasia. En general requieren resección completa de la vía biliar con la derivación biliodigestiva correspondiente.
Pronóstico
El pronóstico del colangiocarcinoma y el cáncer de vesícula biliar es generalmente malo, especialmente para el cáncer de vesícula biliar y el colangiocarcinoma intrahepático.
Colangiocarcinoma: tasa de supervivencia a 5 años después de una resección curativa
♦ ∼ 16-44% para los tumores de las vías biliares intrahepáticas
♦ ∼ 20-30% para los tumores de las vías biliares extrahepáticas
El tumor benigno quístico más frecuente del hígado es el quiste hepático simple El tumor sólido benigno más común es el hemangioma.
El tumor maligno más frecuente, localizado en el hígado corresponde a las metástasis, usualmente provenientes de vísceras abdominales que drenan en la vena porta (cáncer de colon). Corresponden a aproximadamente el 90% de tumores malignos que se pueden localizar en el hígado.
El tumor maligno primario más frecuente es el hepatocarcinoma, proveniente de los hepatocitos. Asimismo, se pueden encontrar, en menor frecuencia, neoplasias malignas en la vía biliar intrahepática, correspondientes a colangiocarcinomas (ESSALUD 2001)
Cirrosis hepática: 80% de los casos
Hepatitis B o C
Enfermedad hepática alcohólica
Esteatohepatitis no alcohólica
Hemocromatosis
Enfermedad de Wilson
Clínica (ESSALUD 2004):
Deficiencia de alfa-1 antitripsina
Enfermedades autoinmunes hepáticas (Hepatitis autoinmune)
Esquistosomiasis
Ingestión crónica de alimentos contaminados con aflatoxina (carcinógeno producido por Aspergillus flavus)
Generalmente asintomático, aparte de los síntomas de la enfermedad subyacente (principalmente cirrosis o hepatitis)
Posibles síntomas de enfermedad avanzada
♦ Pérdida de peso, anorexia.
♦ Hepatomegalia y dolor a la palpación en el cuadrante superior derecho
Síndromes paraneoplásicos:
♦ Policitemia, hipoglucemia, hipercalcemia
Exámenes:
Ecografía: la mejor prueba inicial
♦ Bordes de masa irregulares
♦ La ecogenicidad varía de homogénea a heterogénea y de hipoecoica a hiperecoica
TAC abdominal (con contraste): prueba confirmatoria
♦ Lesiones hipodensas (únicas o multifocales)
♦ Bordes de masa irregulares
♦ Posible invasión local
♦ Ictericia
♦ Ascitis
♦ La invasión vascular del tumor puede ser visible (p. Ej., Trombosis de la vena porta )
♦ Es posible que se observe cirrosis subyacente
♦ Mejora de contraste rápida y vívida durante la fase arterial tardía, seguida de un lavado rápido
♦ Permite realizar la biopsia (diagnóstico definitivo)
El marcador tumoral más importante corresponde a Alfa Feto Proteína (AFP).
La cirugía resectiva es el procedimiento de elección, sin embargo, aplica solo para pacientes con ciertas características, como tamaño del tumor y estado general del paciente.
En neoplasias pequeñas y únicas se puede realizar tumorectomía o segmentectomía.
En neoplasias múltiples está indicado el trasplante hepático.
Otros procedimientos de menor pronóstico son la embolización del tumor, la ablación, la inyección percutánea de etanol y tratamientos quimioterápicos.

Figura 96 Carcinoma hepatocelular TC abdominal con contraste (vista axial) Se puede ver una masa hepática hipodensa sin una demarcación clara con el tejido hepático sano.

La neoplasia de la cabeza de páncreas es la localización más frecuente (65% de los casos) (ESSALUD 2001)
Más común: adenocarcinoma ductal (95%)
Edad > 50 años, consumo de alcohol, tabaco, obesidad, diabetes mellitus, procesos inflamatorios crónicos del páncreas (pancreatitis crónica > 20 años).
Clínica (ESSALUD 2006, 2012, 2015): La triada característica consiste en la baja de peso, ictericia y dolor. La pérdida de peso es el hallazgo más precoz. La presencia de triada es sugestiva del cáncer de cabeza de páncreas u otros tumores periampulares (como el ampuloma, cáncer de duodeno o colangiocarcinoma distal).
Exámenes:
TAC o ecografía endoscópica con toma de biopsia
Al examen físico, puede estar presente el signo de Courvoisier Terrier (palpación de la vesícula biliar dilatada no dolorosa) (ENARM 2009, ENARM 2012).
Los tumores ubicados en otras zonas como el cuerpo y cola no suelen cursar con ictericia.

Síndrome de Trousseau: tromboflebitis superficial (en el 10% de los casos)
Colangiopancreatografía por resonancia magnética (CRM) / endoscópica (CPRE)
♦ Para descartar coledocolitiasis
♦ Evaluar si está indicada la descompresión biliar (p. Ej., En tratamiento paliativo para aliviar los síntomas) El marcador tumoral CA-19.9 ayuda como seguimiento (ENARM 2014).
Dependerá de la progresión de la enfermedad.
Tratamiento curativo: se realiza la cirugía de Whipple que consiste en la resección del duodeno y cabeza del páncreas. Esta se asocia a alta tasa de mortalidad.
Tratamiento paliativo: consiste en derivaciones biliodigestivas (ENARM 2002).
Curso muy agresivo:
Tasa de supervivencia general a 5 años: 10%
Tasa de supervivencia a 5 años del cáncer de páncreas metastásico: ∼ 3%